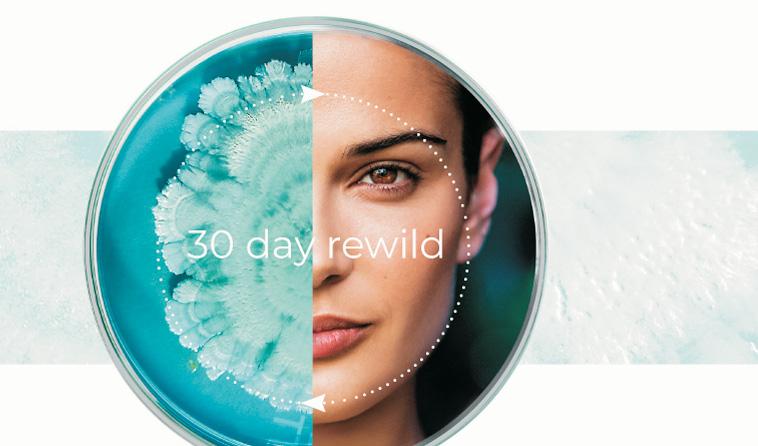
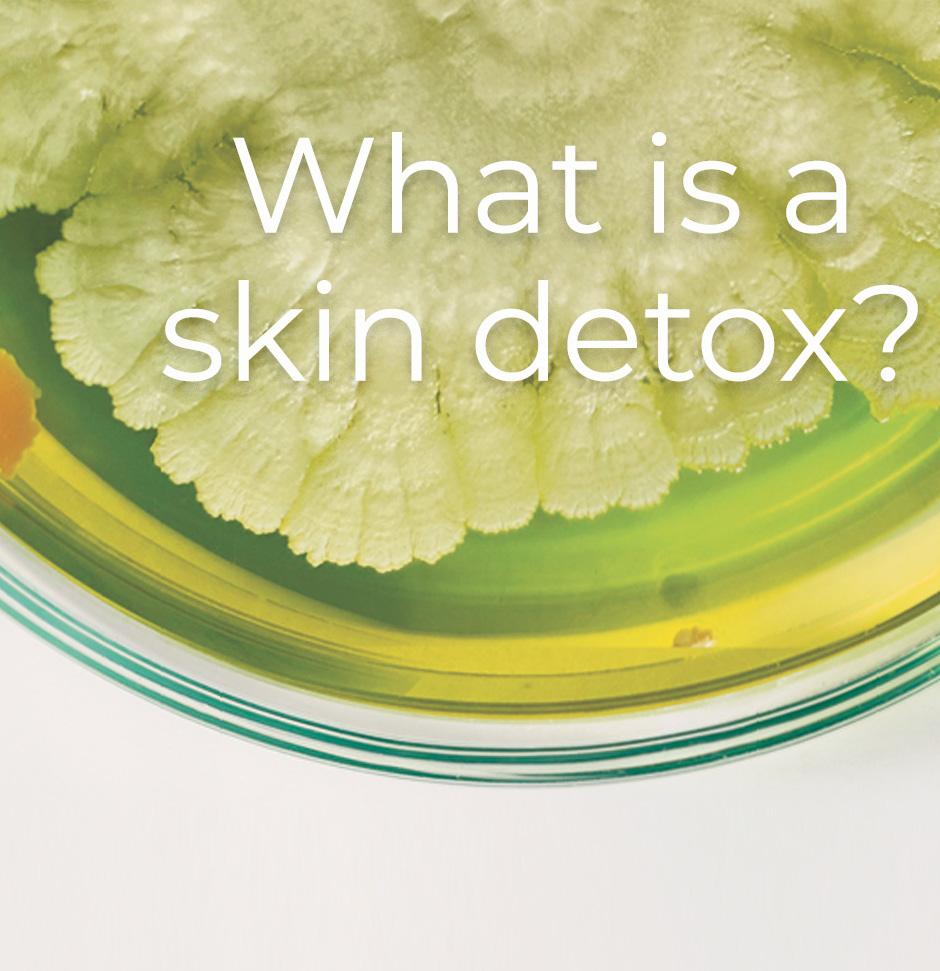
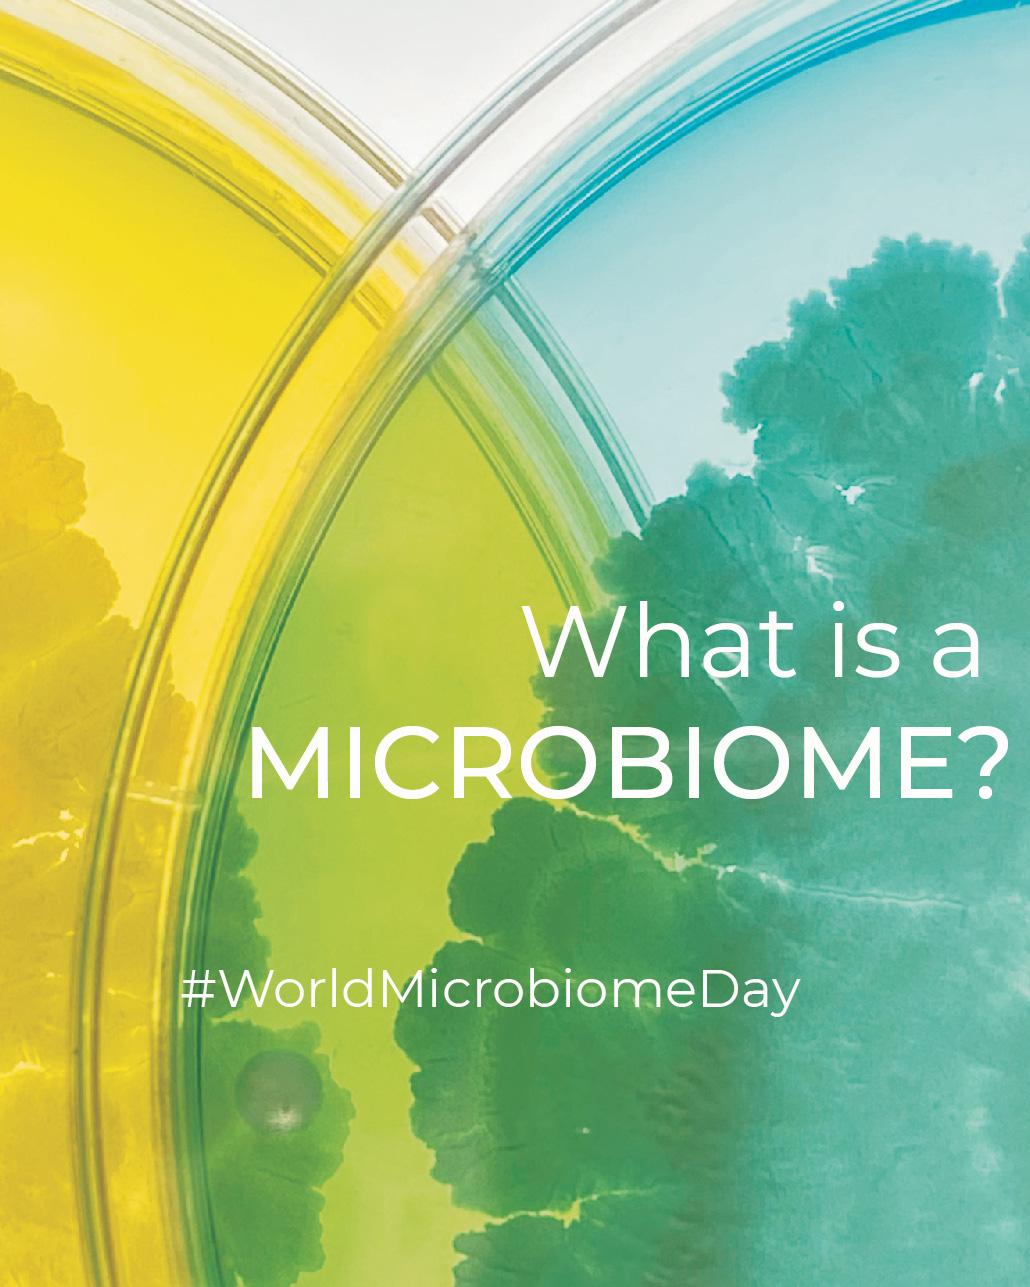

Doc: Le Parc Hôtel & Yonaguni Spa, Alsace, FRANCE
Global Wellness Economy 2
Beyond Relaxation 4
Micronised Marine Algae - Thalgo la Beaute 6
Spa Industry Insights: Dr Nadine de Freitas 8
Nervous System Regulation 10
The Spa Warehouse: Two Decades of Excellence 12
Tribute to Trevor Steyn: Founder of Esse Skincare 14
Science Meets Sensory 16
VinoCeuticals® 8-in-1 RESVERATROL PowerComplex 18
Resonating Sound Wellness 20
The ANESI Lab Revolution 22
Biomedical Emporium 10th Anniversary 24
Lamelle Pharmaceuticals launches Matricoll ECM 26
Biologique RechercheVIP O2 28
Inflammageing: The Skin's Silent Saboteur 30
Professional Skin Care Lab Celebrates 25 Years 32
Embracing Ageing Well 34
Resa.K Skin Science 36
Nouveautés 38
Ageless by Design 40
Athlete Recovery 42
Timing in Recovery 44
Infrared Therapy 46
Popsicle Nail Bar 48
Mind-Body Awareness with Access Bars 50
NEXT I HEALTH 52
IVGo: Bringing Mobile IV Wellness to Your Door 54

Nouvelles Esthetiques















This issue is, at its core, a celebration — of milestones reached, of longevity earned, and of an industry that continues to refine its purpose. From landmark anniversaries to new innovations, we honour the people, brands and philosophies that have helped shape professional spa and wellness across the region.
Threaded through these pages is a clear, shared theme: the evolution of spa therapies themselves. No longer defined by indulgence alone, today’s treatments reflect a deeper understanding of the body, the nervous system, skin biology and recovery. Spa therapies are becoming quieter, more intentional and more intelligent — designed not to impress, but to restore.
As science and sensory experience move closer together, therapists are reclaiming their role as skilled interpreters of wellbeing, guiding guests toward treatments that support lasting health rather than momentary escape. At the same time, spas are emerging as spaces of recalibration — places where care, expertise and presence matter deeply.
This issue celebrates an industry in alignment: grounded in knowledge, softened by humanity, and confident in the power of meaningful spa therapies.
Enjoy the read !
www.nouvelles-esthetiques.com I Fondateur: H. Pierantoni I Directeur de la Publications: Jeannine Cannac-Pierantoni
Romania
Singapore • South Africa • Spain • Taiwan • Turkey • Ukraine • USA • Yugoslavia
Dr. Nadine de Freitas e-mail: nadine@maxcafe.co.za
Dr Nadine de Freitas e-mail:

a Record $6.8 Trillion and Is
The Global Wellness Institute (GWI) released the Global Wellness Economy Monitor 2025, the only research that provides authoritative, in-depth data and insights on the global wellness market and each of its 11 sectors.
The story emerging from the data: continued, accelerating growth. The wellness market has doubled since 2013, and grew 7.9% from 2023 to 2024, reaching a new peak of $6.8 trillion. The market is officially beyond “pandemic recovery mode”: all 11 wellness sectors now exceed their 2019 values, most by significant margins. By far the fastest growing segments are wellness estate and mental wellness, expanding at 19.5% and 12.4% annually, respectively, from 2019 to 2024. The only stagnant market: workplace wellness, with global spending shrinking by 1.5% from 2023 to 2024. Every regional wellness market has experienced major growth over the last five years, with North America (7.9%), Middle East-North Africa (7.2%) and Europe (6.3%) posting the biggest annual gains.
Wellness ($6.8T) now surpasses other global megaindustries, including sports ($2.7T), tourism ($5T), the green economy, ($5.1T), and IT ($5.3T). It's almost four times bigger than the pharmaceutical industry ($1.8T) and is 60% as large as all global health expenditures (including consumer and government spending of $11.2T). Wellness keeps growing its share of the overall world economy: if it represented 5.7% of global GDP in 2019, and 6.1% in 2024, GWI forecasts that it will comprise 7.1% by 2029.
Because the trends fueling the wellness industry will only accelerate-an aging population, rampant chronic disease and mental unwellness, and a market newly focused on prevention and longevity--GWI predicts that the industry will grow at an even faster pace (7.6% annually) through 2029, when it will approach $10 trillion. The predicted biggest gainers through 2029 by annual growth rate are wellness real estate (15.8%), traditional & complementary
medicine (10.8%), mental wellness
and thermal/mineral springs (10%).
“Now that the wellness economy has fully recovered from the pandemic, we can see how unstoppable it is as a consumer trend, and also how much the future growth has been accelerated by our pandemic experiences,” said Katherine Johnston, GWI senior research fellow. “There's been a sea change in consumer mindsets, with prevention, mental health, social connection, the impacts of our living environments, and nature becoming dramatically more important all over the world. These shifts are fueling growth across all wellness sectors--from wellness real estate and mental wellness to hot springs and social bathing to more sophisticated preventative medical-wellness solutions.”
The fastest-growing market over the last five years is wellness real estate (19.5% annually), as the pandemic ignited a new awareness about the extraordinary impact that external environments have on our physical and mental health. The #2

growth star: mental wellness (12.4% annually), as people face increasingly immense stresses, and because for younger generations, mental wellbeing is non-negotiable. The US mental wellness market ($125 billion) dwarfs all other countries, with China a distant second at $16 billion. Mental wellness segments with powerful annual growth these last five years were cannabis products (26%), meditation and mindfulness (18.9%), and sleep (12.6%).
Four markets fall into the “mature and steady growth sectors”: personal care and beauty; healthy eating, nutrition and weight loss; physical activity; and traditional and complementary medicine, all of which experienced strong (roughly 5%) annual growth from 2019 to 2024. The tourism-based wellness sectors were hit hard by the pandemic but roared back between 2023 and 2024: wellness tourism grew 13.8%, spas 14.6%, and thermal/mineral springs 11.1%, making them three of the four largest yearover-year gainers, along with wellness real estate. Workplace wellness stands out for its lack of growth, as more employers move away from programmatic approaches to employee wellness and the surge in remote and “gig” work leaves more employees without access to such benefits.
Per capita spending on wellness is dramatically higher in North America ($6,029) and Europe ($1,876) compared to other regions like Latin America-Caribbean ($607), Asia ($471) and the Middle East-North Africa ($339).
Wellness real estate will remain the #1 growth leader (15.2% annual growth), doubling in size in the next five years, just as it did in the last five. Notable: traditional and complementary medicine is projected as the #2 future gainer (10.8% annually), not only because Ayurveda, TCM and herbal medicines are getting infused in ever more supplements/products, but because the category includes the spawning longevity and biohacking approaches--from infrared light therapy to cryotherapy to IV drips--now ubiquitous in fitness/wellness centers, spas and resorts.
Both mental wellness (10.1%) and wellness tourism (9.1%) will see powerful annual growth. The thermal/mineral springs market will be a future standout (10% annual growth) as hundreds of springs-based destinations are in the global investment pipeline and social bathhouses and water-based destinations are a huge global trend.
Also to watch: within the “public health, prevention and personalized medicine” segment, the now $147 billion personalized medicine market is expected to see a rapid 9.3% yearly growth through 2029, as longevityseeking consumers rush to diagnostic services and personalized health optimization.
By 2029, six wellness sectors-personal care & beauty; healthy eating, nutrition, & weight loss; physical activity; wellness tourism; wellness real estate; and traditional & complementary medicine-will exceed $1 trillion in market size.
Research Sponsors: This research was made possible by these leading companies: Aldar Properties PJSC, Amway, Fountain Life, Sable Investments, Therme Group, Eywa by R Evolution, Hyatt, NADclinic, Carillon Miami Wellness Resort, Technogym, amp, KOHLER, Mather, Rancho la Puerta, Six Senses and Universal Companies.
About the Global Wellness Institute: The Global Wellness Institute (GWI), a nonprofit 501(c)(3), is considered the leading global research and educational resource for the global wellness industry and is known for introducing major industry initiatives and regional events that bring together leaders to chart the future. GWI positively impacts global health and wellness by educating public institutions, businesses and individuals on how they can work to prevent disease, reduce stress and enhance overall quality of life. Its mission is to empower wellness worldwide.




For decades, the spa was defined by indulgence - a place to escape, soften, and momentarily forget the outside world. Today, that definition is evolving. The strongest trend shaping modern spa therapies is not a single modality or innovation, but a profound integration of science, sensory experience, and emotional wellbeing. As lifestyles accelerate and stress becomes chronic, spas are redefining their role: no longer simply places of relaxation, but sanctuaries for nervous system regulation, resilience, and restoration.
This shift reflects a deeper understanding of what modern guests truly seek. Relaxation alone is no longer enough. Clients are arriving depleted, overstimulated, and emotionally fatigued - looking for therapies that restore balance on a physiological, psychological, and sensory level. In response, spas are curating experiences that are evidence-informed, deeply immersive, and emotionally intelligent.
One of the most significant evolutions in spa therapy is the focus on nervous system regulation. Stress is no longer viewed as a fleeting state but as a constant background condition affecting sleep, immunity, digestion, hormonal balance, and mental health. Modern spas are responding with treatments designed to activate the parasympathetic nervous system, allowing the body to shift from survival mode into repair.
Slow, rhythm-based massage, craniosacral techniques, breathwork-infused body treatments, sound therapy, and guided stillness rituals are becoming central to spa menus. These therapies prioritise pacing, presence, and sensory safetyencouraging the body to downshift naturally. Rather than overstimulating the senses, the goal is coherence: steady breath, softened muscles, slowed brainwaves, and a sense of grounded calm.
This approach marks a departure from high-pressure, performance-driven treatments toward therapies that restore capacity rather than exhaust it.
Alongside this sensory evolution, science has taken a decisive step into the spa environment. Advances in wellness technology have made once-clinical modalities accessible, elegant, and deeply complementary to hands-on treatments. Touchless therapies, LED light therapy, infrared saunas, PEMF mats, cryotherapy, compression therapy, and robotic massage systems are no longer novelties - they are tools for precision and consistency.
These technologies offer measurable outcomes: improved circulation, reduced inflammation, lymphatic support, muscle recovery, and enhanced cellular function. Importantly, they also support emotional wellbeing by creating predictable, safe, and non-invasive experiences - particularly appealing to guests who prefer minimal touch or are navigating stress, trauma, or burnout.
What distinguishes the modern spa is not technology alone, but how it is integrated thoughtfully into sensory journeys, rather than presented as cold or clinical. Science becomes part of the ritual, enhancing rather than replacing human care.
Sensory experience has emerged as one of the most powerful tools in contemporary spa design. Sound, scent, temperature, texture, and light are no longer background elements - they are therapeutic instruments.
Sound therapy and vibrational rituals are increasingly embedded into spa treatments, using singing bowls, gongs, tuning forks, or curated soundscapes to guide brainwave states and emotional release. Aromatherapy is layered with intention, using neuro-aromatic principles to influence mood, memory, and relaxation. Chromotherapy and soft lighting regulate circadian rhythms and emotional tone, while heated surfaces and hydrotherapy anchor the body in physical comfort.
These multi-sensory environments work synergistically, creating immersive states of presence that are difficult to achieve in daily life. The result is not only relaxation, but a felt sense of safety, coherence, and reconnection.
Perhaps the most meaningful evolution in spa therapy is the acknowledgement of emotional health as integral to wellness. Modern guests are seeking spaces where they can exhale emotionally, not just physically.
Spas are responding with trauma-informed touch, somatic awareness practices, emotional release rituals, and therapies that encourage introspection and self-regulation. Digital detox programs, journaling sessions, creativity workshops, and guided reflection are increasingly woven into spa offerings, recognising that emotional processing is as restorative as physical care.
Group experiences - such as sound baths, breathwork circles, or wellness retreats - offer communal support while maintaining a sense of safety and shared intention. In these settings, guests often find that emotional release feels easier, supported by collective presence rather than isolation.
The integration of science and sensory care has also elevated expectations around personalisation. Generic treatments are giving way to tailored experiences informed by consultation, diagnostics, and lifestyle awareness.
Skin analysis, body mapping, wellness questionnaires, and goal-oriented planning allow therapists to curate treatments that meet guests
where they are - physically, emotionally, and energetically. This personal approach fosters trust and long-term engagement, transforming the spa visit into an ongoing wellness relationship rather than a once-off indulgence.
As the boundaries between wellness, healthcare, and lifestyle continue to blur, the modern spa is emerging as a sanctuary of regulation and resilience. It is a space where overstimulated minds can soften, exhausted bodies can recover, and emotional tension can be safely released.
This evolution reflects a broader cultural shift: from doing more to being more; from quick fixes to sustainable wellbeing; from external performance to internal balance. Spas are uniquely positioned to meet this need, offering environments that honour both ancient wisdom and modern science.
The future of spa therapy lies not in chasing trends, but in deep integration - blending evidence-based modalities with sensory intelligence and emotional awareness. As guests become more discerning, the spa's role will continue to expand: not just as a place of beauty or luxury, but as a vital contributor to holistic health.
In this new era, the spa is no longer an escape from life - it is a place to relearn how to live well.

If you ever feel lacking in Vital Energy, Energising Light, Comforting warmth… it could be because you are far from the Mediterranean Coastline.
For over 60 Years, Thalgo have harnessed the power of the Ocean, to create the perfect fusion of Efficacy and Wellbeing.
In 1966, André Bouclet, Thalgo's founder, Patented a combination of three Micronised Marine Algae, the Mineral Composition of which is very similar to Skin. Developing and Patenting a Micronisation Technology that ruptures Algae's outer cell wall without damaging the active compounds concentrated at the heart of the Cell, he obtained an Algae Powder with an as yet unequalled Wealth of Micronutrients. The same Year, he filed a Medical Patent describing the Therapeutic Benefits of Thalgo Micronised Marine Algae.
MICRONISED MARINE ALGAE POWDER
100% Marine and directly Assimilable nutritional richness.
In addition to their wealth of revitalising essential trace elements and minerals, Thalgo Micronised Marine Algae contain numerous micronutrients that can be directly assimilated by the epidermis. They boast 20 Amino Acids (9 of which are Essential) and structuring Fatty Acids (including Omega-6s) to strengthen Skin Tissue. They contain stimulating Vitamins (B, C, E and pro A) and Sugars with an Energising action. Last but not least, they supply Antioxidant carotenoids (Chlorophyll and Xanthophyll) and Polyphenols with a protective Anti-Free Radical action.
Thalgo Micronised Marine Algae Powder replenishes minerals and revitalises body and skin, even far from the sea.
MICRONISED MARINE ALGAE FILTRATE
A Biocompatible Fortifying and Remineralising
Marine Complex. A filtered Aqueous extract obtained from Thalgo Micronised Marine Algae Powder, the Filtrate concentrates the main remineralising Minerals and Trace elements and energising, fortifying and protective Micronutrients to revitalise Skin on a daily basis. These Marineorigin essential Micronutrients are highly compatible with our body and can be directly assimilated by skin. Thalgo Micronised Marine Algae Filtrate revitalises and strengthens skin on a daily basis.
Not only have Thalgo created the incredible MMA Powder and Filtrate - they have also created a 'Marine Peel'. Active enough to show results from the first treatment, whilst still maintaining the skins integrity - no sensitivity - no down time!
Combining Fermented Micronised Marine Algae with Lactic Acid, this 'New Skin Effect' treatment comes in 3 progressive Grades:
Grade 1 - Restrict enlarged pores, Increase Radiance and Microcirculation
Grade 2 - Target Deeper wrinkles, and stimulate Collagene and Elastin Synthesis
Grade 3: Targeting Photo-Ageing, Pigmentation and overall Skin quality
At the Thalgo Laboratory in the Soth of France, the Thalgo team of Scientists, Biochemists and Pharmacists have made sure that all extraction methods are natural, no chemicals are used, and all biproducts of extraction are completely safe for the Environment.
All tests are done in-vitro and in-vivo - as well as a new way of testing on Algae - ensuring every product is completely safe for the Ocean and our Skin.
For further information, visit our website www.thalgo.co.za






Spa therapies are no longer defined solely by the treatment room. They are shaped by how people are living, how they are coping, and what they are quietly asking for when they step into a wellness space. Over the past few years, the spa has evolved from a place of occasional indulgence into something far more essential: a space for recalibration, recovery, and reconnection. This shift has changed not only what treatments are offered, but how they are experienced, delivered, and remembered.
What is most noticeable today is a move away from spectacle and toward substance. Guests are less interested in novelty for novelty’s sake and more drawn to therapies that feel purposeful, grounded, and genuinely restorative. There is a growing appreciation for treatments that work with the body’s natural rhythms rather than attempting to override them. Massage, once considered a simple luxury, is being re-understood as a powerful regulator of the nervous system. Facial therapies are increasingly expected to support long-term skin health, not just deliver an immediate glow. Even the simplest rituals are being elevated through intention, precision, and care.
At the same time, there is a clear desire for personal relevance. Spa guests no longer want to choose from a long, generic menu; they want to feel seen, listened to, and guided. Therapists are becoming
interpreters rather than performers, shaping experiences around individual needs, energy levels, and emotional states. This has brought a renewed respect for professional expertise, as well as a shift toward more tailored treatment journeys that evolve over time instead of offering one-off solutions.
Science has quietly taken a more central role in this evolution. Without becoming overly clinical, spa therapies are increasingly informed by a deeper understanding of skin biology, stress physiology, and recovery processes. Guests are more informed and curious than ever before, and they respond to treatments that make sense on a biological level. When therapies align with how the body actually functions, the results feel more authentic, more sustainable, and more satisfying.
Yet, as science advances, there is also a strong counterbalance: the need for softness. In a world saturated with information, screens, and constant stimulation, spas are becoming sanctuaries of slowness. Touch, warmth, scent, silence, and rhythm are reclaiming their place as essential therapeutic tools. The most successful spa experiences today are those that blend technical knowledge with emotional intelligence, creating treatments that feel both intelligent and deeply human.
Another significant change is how spa environments are being used. Wellness is no longer confined to
a single hour on a treatment bed. Guests are seeking experiences that extend beyond the therapy itself, whether through longer stays, integrated wellness journeys, or spaces that invite lingering and reflection. The spa is becoming part of a broader lifestyle conversation, connected to travel, recovery, mental health, and everyday wellbeing.
There is also a noticeable shift toward inclusivity and accessibility. Spa therapies are slowly shedding the idea that wellness is exclusive or aspirational. Instead, they are becoming more approachable, more adaptive, and more responsive to different bodies, ages, and needs. This evolution feels less like a trend and more like a long-overdue correction— one that strengthens the relevance and resilience of the industry as a whole.
Ultimately, spa therapies today sit at a meaningful intersection. They are shaped by science, softened by care, and guided by an increasing awareness of what people truly need in order to feel well. The future of spa is not louder, faster, or more complicated. It is calmer, smarter, and more intentional. And in that quiet confidence, spa therapies are finding their most powerful voice yet.





In the evolving world of spa and wellness, the focus is shifting from indulgence alone to nervous system regulation - the science-backed practice of restoring balance to the body and mind. Modern spa-goers arrive seeking more than temporary relaxation; they are looking for therapies that actively reduce stress, enhance recovery, and cultivate long-term resilience. This approach reflects a deep understanding of human physiology, psychology, and the increasingly recognized connection between stress, health, and longevity.
“Wellness today is measured not just in how relaxed you feel, but in how your body and mind recover and restore balance.” - Dr Nadine de Freitas
The nervous system is the body's communication network, controlling everything from heart rate and digestion to stress response and sleep. In modern life, chronic stress, overwork, and constant digital stimulation keep the body in a persistent state of sympathetic dominance - the fight-or-flight mode. Over time, this can lead to anxiety, poor sleep, hormonal imbalance, digestive issues, and weakened immunity.
Spas are increasingly recognizing that true wellness begins here. By supporting the parasympathetic nervous system, the body can switch from reactive stress responses to a restorative state. This shift is not merely a luxury; it is a vital intervention for physical and emotional health.
Traditional relaxation techniques - a hot bath or gentle massage - are helpful, but modern nervous system-focused therapies are more precise. Parasympathetic activation aims to slow the heart rate, deepen breathing, release muscle tension, and reduce stress hormone levels.
Therapies now include:
• Rhythm-based massage techniques, which use consistent, fluid movements to calm both body and mind.
• Craniosacral therapy, a gentle touch method that regulates cerebrospinal fluid and encourages systemic relaxation.
• Breathwork-infused rituals, guiding the body into deeper states of coherence and balance.
• Sound therapy, using vibrational frequencies to influence brainwave patterns and nervous system function.
These interventions allow the body to restore itself at a cellular level, improving sleep, reducing inflammation, and promoting emotional calm.
Modern spas are no longer focusing solely on physical outcomes. Nervous system regulation addresses the emotional and psychological dimensions of wellbeing. Many treatments create environments of safety and sensory comfort, enabling guests to release suppressed tension and experience mental clarity.
Guided reflection, journaling, or mindfulness sessions are often paired with bodywork, amplifying the therapeutic effect. Guests leave feeling mentally lighter, emotionally balanced, and physically restored - a comprehensive approach that elevates the spa experience from indulgence to meaningful wellness.
The spectrum of nervous system-focused treatments is expanding rapidly:
• Floatation therapy: Sensory deprivation tanks reduce external stimuli, helping the nervous system recalibrate and facilitating profound relaxation.
• Infrared saunas and heat therapy: Improve circulation, relax muscles, and enhance detoxification while encouraging parasympathetic activation.
• Touchless therapies and/or robotic massage: Offer precision, consistency, and measurable results, which can reduce anxiety for guests sensitive to human touch or overstimulation.
Even traditional therapies such as Swedish massage, hot stone, and lymphatic drainage are being recalibrated with nervous system principles, focusing on pacing, pressure, and sensory environment to optimize restorative outcomes.
Interestingly, the concept of using touch, rhythm, and sensory modulation to restore balance is ancient. Ayurvedic and Traditional Chinese Medicine practices have long emphasized massage, breathwork, sound, and temperature therapies to harmonize bodily systems. Modern spa therapies build on these principles but combine them with research-driven insight into the autonomic nervous system, neurochemistry, and physiology, creating treatments that are both ancient in wisdom and contemporary in precision.
Guests increasingly expect tangible outcomes alongside subjective wellbeing. Nervous systemfocused spa therapies deliver measurable improvements:
• Lowered cortisol and stress hormone levels
• Reduced heart rate and blood pressure
• Enhanced sleep quality
• Improved muscular relaxation and joint mobility
• Heightened emotional resilience
By integrating assessment tools, wellness questionnaires, and follow-up consultations, spas ensure that interventions are both effective and tailored to individual needs. This creates trust and encourages ongoing engagement, transforming one-off visits into sustained wellness journeys.
Ultimately, spas are becoming sanctuaries for restoration. They are spaces where the nervous system can reset, the mind can quiet, and the body can recover. By prioritizing nervous system health, spas shift their role from passive indulgence to active wellness facilitation.
This evolution represents a broader cultural shift: in a world of constant stimulation and chronic stress, the true luxury is not more activity, but capacitythe ability to recover, restore, and engage fully in life.
“When the nervous system finds balance, the body, mind, and spirit align - and wellness becomes more than a fleeting moment of calm; it becomes sustainable vitality.”





As The Spa Warehouse celebrates its 20th anniversary, the milestone feels less like a moment of reflection and more like a confident pause before the next chapter unfolds. Widely recognised as one of Africa’s leading spa consulting, design, and procurement specialists, the company has spent two decades shaping some of the continent’s most refined wellness destinations — with an approach grounded in integrity, precision, and a genuine respect for the people who operate them.
To mark this significant occasion, Les Nouvelles Esthétiques & Spa Magazine sat down with founder Jacoline Wentzel to reflect on the company’s journey, key milestones, and the evolving vision guiding The Spa Warehouse into its next decade.
The 20-year celebration has been marked by two standout developments that speak clearly to The Spa Warehouse’s growth and strategic direction. The first is the relaunch of its proprietary spa brand, now known as African Cashmere — a refined, sensorially driven product line rooted in African luxury and elevated wellness rituals. The second is the opening of the luxury spa at Morea House, South Africa’s first Marriott Autograph Collection Luxury Hotel, a project that has set a new benchmark for hospitalityled wellness in the region.
“These projects are deeply symbolic,” Jacoline explains. “They reflect who we are today — not just as consultants, but as custodians of quality, experience, and long-term sustainability in spa development.”
Together, these launches underscore The Spa Warehouse’s enduring legacy and its ongoing commitment to shaping the future of luxury spa and wellness across Africa.
From a Beachside Vision To a Continental Footprint
The origins of The Spa Warehouse are both personal and quietly powerful. In 2005, Jacoline made a deliberate decision to step away from corporate life and relocate to Cape Town, drawn by the desire for balance, creativity, and purpose.
“I remember lying on Clifton 4th Beach one afternoon,” she recalls. “I began imagining a business that could serve the spa industry in a holistic way — a one-stop solution where operators didn’t have to juggle multiple suppliers, consultants, and contractors.”
What began as a simple idea soon evolved into a

fully integrated spa consultancy, design, and procurement enterprise. Over the years, The Spa Warehouse has steered projects across South Africa, Mauritius, and selected African markets, earning a reputation for discretion, excellence, and an unwavering commitment to detail.
“That day on the beach feels like a lifetime ago,” she says with a smile. “But the heart of the vision has remained the same — to support spas in building environments where both guests and staff can truly thrive.”
While the company’s portfolio now includes some of the region’s most prestigious wellness destinations, Jacoline points to an early milestone as particularly formative.
“Our very first spa consulting client will always stand out,” she explains. “It set the trajectory for everything that followed and became the blueprint for how we operate today.”
This consulting-led focus has since guided The Spa Warehouse’s involvement in several high-profile projects, including Terre Paisible Medical Rejuvenation & Spa, the Spa at Erinvale Hotel, and most recently, the spa at Morea House. Each project reflects a tailored approach — balancing concept, design, operational flow, and long-term performance.
“These projects were not just highlights,” Jacoline notes. “They were deeply rewarding collaborations where excellence, trust, and shared vision came together.”
When asked about the guiding principle behind The Spa Warehouse, Jacoline’s answer is immediate and grounded. “We have a true heart for this industry,” she says. “We don’t believe in volume for the sake of growth. We believe in quality, uniqueness, and bespoke service.”
This philosophy translates into a highly hands-on approach across all consulting projects. From early concept development to procurement, installation, and post-opening support, The Spa Warehouse remains closely involved — ensuring that each spa is not only beautiful, but functional, sustainable, and aligned with its operational realities.
“Every spa has its own story,” she adds. “Our role is to help tell that story through space, flow, materials, and experience.”

For Jacoline, success is measured far beyond financial milestones or accolades. “I see myself as an intercessor for this industry,” she reflects. “I stand up for spa managers and therapists, ensuring that facilities are of the highest quality the budget allows.”
This advocacy-driven mindset has become one of The Spa Warehouse’s defining strengths. Jacoline speaks passionately about working alongside spa teams during setup and beyond opening — helping them settle in, refine operations, and ultimately thrive.
“Success, for me, is seeing the smiles of staff when they walk into a space designed with their wellbeing in mind,” she says. “It’s when a client hugs you at the end of a project, grateful not just for the spa itself, but for the journey and care that went into creating it.”
As The Spa Warehouse looks toward the next decade, the focus remains clear: excellence, evolution, and intentional growth.
“Some things will never change,” Jacoline confirms. “We will always offer hands-on consulting and procurement, and we will always prioritise quality.”
At the same time, the company is leaning more deeply into wellness-led design, with an increased emphasis on holistic experiences, longevity, and meaningful guest journeys. Expansion into additional African markets — including Ghana, Namibia, and Botswana — is already underway through select luxury projects.
Further developments include the continued growth of African Cashmere into the wellness and amenity space, broader distribution across African spas, and the expansion of The Spa Warehouse’s locally manufactured spa furniture range, with new designs currently in development. A growing marketing and communications focus will also offer greater insight into the company’s day-to-day journey and project evolution.
“We are excited for what lies ahead,” Jacoline concludes. “We genuinely love what we do, and we are grateful for the way this company continues to grow with purpose. We are excited for the future, as we are loving what God is doing in our company.”
For more information: Visit: www.thespawarehouse.co.za
Tel: +27 66 234 2779

It is with enduring sadness that we reflect on the sudden passing of Trevor Steyn, Founder and CEO of Esse Skincare, on 1 November 2025. Trevor’s passing represents a profound loss, not only for Esse and the team who worked closely with him, but for the wider global community of professionals, partners, and consumers inspired by his vision. His influence shaped Esse and helped redefine how the world understands skin health.
Trevor’s journey began with a deep commitment to organic, sustainable skincare. In the early days of Esse, he formulated some of the first Ecocertcertified moisturisers in South Africa — products so pure and delicate that they had to be kept refrigerated to maintain the integrity of their natural actives. These humble beginnings reflected his uncompromising dedication to quality, ethics, and biological compatibility, and set the foundation for the revolutionary work that would follow. Even

at this early stage, it was clear that Trevor’s vision extended beyond products — he was cultivating a philosophy of skincare as ecology.
A chemist by training and an entrepreneur at heart, Trevor was widely recognised as one of the leading scientific voices in probiotic and microbiome-based skincare. Long before the microbiome became a mainstream conversation, he challenged conventional cosmetic chemistry and championed the view that healthy skin starts with supporting the microbes that protect it. His pioneering work laid the foundation for a new era of personalised, microbiome-driven skincare — one rooted in ecology, sustainability, and scientifically rigorous innovation.
Under Trevor’s leadership, Esse became the world’s first skincare brand to incorporate live probiotics into topical formulations, reshaping industry



standards and inspiring a wave of microbiomefocused research. These innovations were not just clever formulations — they were a scientific revolution in how we understand skin, bridging biology, ecology, and practical wellness. His approach was always grounded in science but delivered with exceptional care for the planet and for the people his work touched.
Trevor’s impact extended far beyond the laboratory. He believed in creating products that were ethical, sustainable, and truly beneficial. He protected biodiversity both on the skin and in nature, consistently leading Esse with a rare blend of purpose, innovation, and integrity. Colleagues recall his curiosity, generosity, and humility — a man equally comfortable discussing molecular pathways as he was mentoring his team or engaging with clients.

The global wellness community quickly recognised Trevor’s work as transformative. From humble beginnings in South Africa, Esse expanded into over 40 countries, embraced by dermatologists, aestheticians, and spa professionals worldwide. The brand’s products are celebrated not only for efficacy but for a philosophy that prioritises health over appearance, ecology over convenience, and biology over aesthetics.
Trevor’s legacy extends beyond formulations and industry accolades. He leaves behind a global paradigm shift in skin health — a legacy of curiosity, courage, and mentorship. His influence will continue through the global community of professionals he inspired, the clients whose skin and confidence he transformed, and the team at Esse who carry his ethos forward every day.
On a personal note, Trevor was a man I respected


deeply. From the earliest days of Esse, I witnessed his commitment, curiosity, and integrity. He was not just a visionary in science; he was a remarkable human being whose humility and generosity made a lasting impression on everyone who knew him. The world of skincare, wellness, and beyond has lost an extraordinary pioneer, but his principles, vision, and the standards he set will continue to guide us all.
Esse’s mission — to support resilient, thriving skin through sustainable, biologically intelligent skincare — will continue as a living tribute to Trevor’s life’s work. The philosophy that healthy skin begins with supporting the body’s natural ecosystem remains at the core of every formulation, ensuring his vision endures.
For more information: www.esseskincare.com

“Trevor Steyn was more than a visionary — he was a man whose integrity, brilliance, and kindness shaped an entire industry. I will always hold mmense respect for him and his work.”
Dr Nadine de Freitas



The modern spa is evolving rapidly, moving beyond traditional massage and relaxation rituals into a sophisticated fusion of science, sensory experience, and personalised care. Guests today are seeking more than indulgence; they are seeking precision, measurable results, and immersive experiences that address both body and mind. Technology is no longer an external addition - it has become a central pillar of contemporary spa design, seamlessly integrated with human expertise to enhance wellness outcomes.
“When science and sensory design converge, the spa transforms from a place of indulgence into a laboratory of wellness and restoration.”
Modern wellness travellers are increasingly informed. They expect treatments backed by research, data, and clinical insight. Science-driven spa technologies provide tangible outcomes: improved circulation, reduced inflammation, enhanced lymphatic function, accelerated recovery, and optimized cellular health.
Some of the most impactful innovations include:
• LED and red-light therapy: Stimulates collagen production, reduces inflammation, and promotes cellular repair.
• PEMF (Pulsed Electromagnetic Field) therapy: Enhances circulation, supports bone and tissue repair, and reduces fatigue.
• Infrared and thermal technologies: Improve muscle relaxation, detoxification, and nervous system modulation.
• Robotic and touchless massage systems: Deliver precise pressure and movement, mapping the body in real-time to tailor treatments to individual needs.
These modalities combine science, accuracy, and consistency, ensuring that every session is safe, effective, and repeatable.
The true power of modern spa technology lies in its integration with sensory design. While machines provide measurable physiological effects, multisensory environments amplify emotional and psychological benefits, creating experiences that feel intuitive, immersive, and deeply restorative.
• Soundscapes and vibrational therapy: Singing bowls, gongs, and curated sound frequencies influence brainwave patterns, calming the mind and enhancing parasympathetic activity.
• Aromatherapy and neuro-aromatics: Scents are chosen for their scientifically observed effects on mood, cognition, and stress modulation.
• Chromotherapy and lighting design: Regulates circadian rhythms and supports emotional tone through carefully curated color sequences.
• Tactile and thermal layering: Heated loungers, hydrotherapy circuits, and textured surfaces provide subtle sensory cues that enhance relaxation and body awareness.
By weaving together these sensory inputs, spas create environments where treatments become fully immersive journeys, supporting emotional, cognitive, and physiological restoration simultaneously.
In the era of smart wellness, one-size-fits-all treatments are no longer acceptable. Modern spa technologies allow for unprecedented levels of personalisation. Robotic massage systems, AI-driven body mapping, and biometric feedback tools enable therapists to tailor every session to a guest's anatomy, tension points, and preferences.
Skin diagnostics, thermography, and functional assessments provide objective data that inform treatment selection. Guests receive customised protocols, ensuring that therapies not only feel effective but are precisely targeted. This approach bridges the gap between traditional spa indulgence and medical-grade outcomes, offering a compelling balance between comfort and measurable wellness.
Take, for example, a hands-off robotic massage session. Sensors map each muscle group and tension point, while AI algorithms adjust pressure, rhythm, and stroke technique in real-time. For the guest, the experience feels intuitive and deeply human, despite the absence of direct touch. The result is a predictable, safe, and reproducible sessionparticularly appealing to clients seeking minimal contact or heightened precision in results.
When combined with ambient sound, calming lighting, and guided breathwork, the therapy becomes a full-body, mind-calming journey. Guests often report reduced muscle tension, enhanced circulation, improved mood, and a profound sense of presence.
Modern spa experiences are defined not by technology alone but by how intelligently it complements traditional practices. Machines and tools extend human capability: they enhance consistency, provide measurable data, and support
recovery. However, they are most effective when paired with skilled therapists, mindful intention, and a holistic treatment environment.
This fusion preserves the human touch - the art of reading a client's needs, creating emotional safety, and intuitively adapting a session - while harnessing the precision and repeatability of technology.
The next frontier in spa innovation lies in integration and customization. Expect more AI-driven diagnostic tools, enhanced biofeedback, and multi-modal treatments that combine light, sound, temperature, and pressure. Wellness will become increasingly tailored to individual physiology, lifestyle, and even genetics, creating spa experiences that are not just restorative but transformative.
At its core, the modern spa is evolving into a wellness laboratory where science and sensory design meet emotional and physical care. Guests no longer visit solely to relax; they arrive to reset their nervous systems, optimise recovery, and achieve measurable results, all within an environment designed for serenity and comfort.
“Technology in the spa is not about replacing therapists - it's about amplifying their skill, precision, and the guest's experience.”
By seamlessly integrating science with sensory experience, modern spas are redefining luxury and efficacy. Treatments are becoming smarter, immersive, and more tailored than ever before, offering results that are measurable, emotional, and deeply restorative - a blueprint for the spa of the future.

Looking to transform your skin’s appearance and health? Who isn’t right…
Look no further and reach for Resveratrol - nature’s free radical reverser!
Resveratrol is a multi-functional powerhouse ingredient boasting protective benefits and the reduction of the effects of aging and adding it to your skin care regimen is as easy as 1, 2, 3. Allow us to introduce the VinoCeuticals® 8-in-1 RESVERATROL PowerComplex
Diminish the 8 visible signs related to aging with this multi-tasking treatment emulsion, leaving skin with a more radiant revitalised appearance. Enjoy visibly younger looking and younger feeling skin with this silk-like super-serum expert.
“As we age, our skin starts to experience thinning as a result of the loss of natural collagen and elastin, but anti-oxidants are able to help safeguard the skin against the accelerated aging linked to free radical damage,” says CEO Lisa Smit who worked to perfect this formulation for more than 4 years.
Of course, enhancing your diet with anti-oxidants will be beneficial, but as much as what we agree that consuming anti-oxidants will increase skin health, the skin care benefits of applying resveratrol directly to the skin will far outweigh that of internal absorption.
One of the main benefits of Resveratrol is its ability to reduce the effects of aging in skin. The topical application of resveratrol has been proven to significantly improve fine lines, wrinkles and the elasticity of the skin in 12 weeks.
Resveratrol is unique in the way that it is able to neutralize free radicals, effectively shielding the skin from harmful environmental aggressors that cause oxidative stress while boosting anti-oxidant levels in the skin, allowing the skin to better defend ánd repair itself.
In addition to free radical protection, Resveratrol has been found to also help protect against UV and blue light damage, preventing the collagen degradation associated with that damage and can contribute to the reduction of pigmentation by regulating melanin production.
A small study also reported that thanks to its calming properties, Resveratrol can help reduce skin inflammation and redness.
In addition to this PowerComplex containing Resveratrol, we’ve further enhanced this emulsion’s multi-tasking approach by including Sodium Hyaluronate.
Although often commonly referred to as Hyaluronic Acid, Sodium Hyaluronate is a derivative of
Hyaluronic Acid and differs in molecular weight. While Hyaluronic acid has a high molecular weight, ‘coating’ the skin and in doing so preventing water loss which leads to better superficial hydration, Sodium Hyaluronate has a lower molecular weight and is small enough to penetrate the epidermis which in turn results in a greater hydration impact from within the skin.
As a skin-conditioning agent, the Sodium Hyaluronate in this preparation forms a soft film on the skin, locking in moisture which leaves it feeling supple and more smooth to the touch.
As a final touch of additional excellence, the expertise of Biosaccharide Gum-1 meticulously helps boost skin comfort and gives this super-serum its ultraluxurious glide and silk-like texture while helping active ingredients stay exactly where they are intended.
With VinoCeuticals® 8-in-1 RESVERATROL PowerComplex, turn back time, blur imperfections and enjoy transformed skin, soft to the touch with a rejuvenated complexion and the appearance of fine lines and wrinkles visibly reduced.
For further information, visit our website www.theravine.co.za

By Almarie Venter: Remind Wellness







In the midst of an ever-expanding global wellness revolution, there exists a resounding call for holistic modalities that resonate with the human spirit and foster well-being on all levels. Among these modalities, sound healing emerges as a timeless practice deeply rooted in ancient traditions yet profoundly relevant in today's modern world.
Sound healing has truly become a passion of mine over the past eight years. Although my career began as a spa and wellness therapist, my personal healing journey with autoimmune ailments has guided me toward alternative and natural medicine. I've experienced profound personal healing and witnessed how sound treatments, both private and group sessions, can shift mental and emotional states, alleviate pain, improve skin appearance, and promote sleep, among other benefits. As a therapist working with sound, one of the best aspects is receiving the therapeutic frequencies while serving clients.
The recent trends and research highlighted by the Sound Wellness Institute reveal a significant rise in interest surrounding sound healing within the spa and wellness industry. The report emphasizes a noticeable increase in demand for sound bath sessions and immersive sound environments aimed at fostering relaxation and meditation, reflecting a growing appreciation for the therapeutic benefits of sound. With sound healing gaining traction, spa and retreat centers are increasingly incorporating this age-old practice into their services, aiming to offer guests a comprehensive healing journey that addresses the holistic well-being of the mind, body, and soul.
Let's explore the science and power of Sound Healing.
Sound healing, an age-old practice spanning diverse cultures, harnesses the therapeutic potential of sound and frequency to restore harmony within the body, mind, and spirit. Supported by scientific research, this holistic modality has garnered recognition for its profound effects on human physiology and psyche.
Sound healing works primarily based on the principles of entrainment and resonant frequency. Entrainment refers to the natural process where a rhythmic pattern induces other organisms to synchronize with it. An evident illustration of this is when we hear music and instinctively start clapping or tapping our feet to its rhythm. However, entrainment can also be employed in more subtle manners. In the realm of sound therapy, it can be utilized to align brainwaves with a slower rhythm, facilitating deep relaxation.
Every object possesses vibrations, and the rate at which these vibrations occur is referred to as its resonant frequency. Picture the body akin to a symphony orchestra, where each component (muscles, bones, organs, cells, etc.) maintains its unique frequency. When in a healthy state, these frequencies harmonize seamlessly. However, when the body's systems are compromised due to physical or emotional factors, certain frequencies are disrupted, causing a literal dissonance. Similar to
an orchestra where one instrument being out of tune affects the overall harmony, every aspect of the body is impacted. Through sound therapy, employing a variety of instruments and tones, the body is gently guided back to its inherent state of equilibrium.
"The resonance of sound and music serves as a potent tool for healing, influencing the cellular structure of the body and altering its vibration. Alongside scientific understanding, lies the profound influence of intention in sound healing. As Jonathan Goldman eloquently summarizes, 'Frequency + intent = healing.' This equation underscores the significance of imbuing sound with healing intentions, amplifying its efficacy to induce profound transformations within us."
Dr. Mitchell Gaynor, a pioneering figure in integrative medicine, elucidates the physiological impact of sound, affirming its ability to modulate the nervous system, reduce blood pressure, lower heart rate, and induce deep states of relaxation. Empirical evidence, as documented in studies such as those published in the Journal of Evidence-Based Integrative Medicine, underscores sound therapy's efficacy in alleviating tension, anxiety, depression, and fatigue while promoting overall well-being.
Integrating Sound Wellness into Spa and Retreat Offerings
Incorporating sound healing into spa and retreat offerings not only enhances the guest experience but also aligns with the evolving landscape of wellness tourism. As travelers seek authentic, transformative experiences that nourish the soul, spa and retreat destinations are poised to play a pivotal role in facilitating healing and self-discovery through the universal language of sound.
Here are some avenues through which sound healing can be incorporated into the spa menu and experiences:
Specialized Massages with Sound Therapy: Enhance traditional massage treatments by integrating sound therapy techniques, such as playing crystal or Tibetan singing bowls on and around the body or using pre-recorded frequency music that enhances relaxation and rejuvenation.
Diverse Sound Modalities: Explore a spectrum of sound therapies, from drum therapy, gong therapy, chanting, or singing.
Sound Beds and Rooms: Design spa facilities equipped with sound beds for VibroAcoustic Sound Therapy and dedicated sound rooms, providing guests with immersive sound healing experiences.
Music and Meditations: Enhance spa treatments with music and guided meditations, creating a sensory-rich environment conducive to relaxation and introspection.
Crafting a Sound Healing Retreat Experience offers spas and retreat centers a unique opportunity to cultivate a sanctuary of healing and rejuvenation, providing guests with a transformative journey of self-discovery and inner renewal. The versatility of sound and its myriad facets allow for boundless creative exploration.
Here are several ideas to craft a memorable and impactful retreat experience:
Sound Bath Immersion: Invite guests to immerse themselves in the healing vibrations of sound baths, featuring crystal singing bowls, gongs, and other instruments that induce deep relaxation and inner harmony.
Guided Meditation, Mindfulness, and Breathwork: Offer guided meditation and breathwork sessions infused with sound, allowing guests to deepen their practice and cultivate inner peace and presence.
Experiential Workshops: Facilitate workshops where guests can explore the therapeutic potential of sound through hands-on activities such as chanting, drumming, and toning, fostering selfexpression and connection.
Personalized Sound Healing Sessions: Provide guests with personalized sound healing sessions tailored to their unique needs, incorporating a blend of sound therapy modalities to address specific concerns and goals.
Nature Immersion and Sound: Integrate sound healing with nature experiences, such as forest bathing or beach meditations, allowing guests to connect with the healing alpha frequencies of nature.
Aqua Sound treatment: The guest float in a heated pool while the therapist play sound bowls in the water.
Salt rooms, Art, Yoga, Tea Ceremonies, Cacao and fire ceremonies pairing possibilities are endless.
Collaborations among spas, hotels, wellness resorts, wellness practitioners, and alternative medicine practitioners pave the way for innovative offerings that integrate sound wellness into wellness retreats, spa treatments, traditional healthcare settings, corporate wellness programs, and schools. By providing integrative sound and energy healing workshops to upskill therapists and empowering wellness teams to embrace new techniques, the industry is positioned to meet the evolving needs of wellness seekers worldwide.
In conclusion, as Nelson Mandela joyfully expressed, "Music is a great blessing. It has the power to elevate and liberate us. It sets people free to dream. It can unite us to sing with one voice." Sound wellness transcends cultural boundaries and speaks to the universal language of the soul, offering a profound pathway toward well-being. As spa and retreat destinations embrace the transformative power of sound, they stand ready to lead the way in fostering holistic wellness experiences that elevate, inspire, and unite humanity.
About Almarie Venter: Remind WellnessIntegrative Wellness Specialist. International trainer/ Signature ritual & treatment development / Holistic Wellness Coach / Sound therapist
For more information: Visit: Remind Wellness u@almarieventer.co.za Whatsapp: 082 924 6314

Anesi Lab is a high-performance cosmeceutical skincare and body-care brand rooted in scientific formulation and professional standards. It is manufactured by Spanish parent company Grupo DRV Phytolab S.L., which has more than 50 years of experience in the professional beauty sector. Anesi Lab's products are developed in its own ISO 9001 and GMP-certified laboratories to guarantee quality, consistency, and excellence from formulation to production.
Anesi Lab specialises in advanced skincare designed for immediate and long term, visible results. Its research and development team selects potent, clinically proven biotechnological and botanical active ingredients that are blended and encapsulated for time-release action, ensuring that formulas work deeply at a cellular level rather than just superficially.
The brand has been present in South Africa for over three decades, building strong partnerships with salons, spas, and aesthetic clinics, and offering ongoing therapist training and support.
Anesi Lab's portfolio spans professional and retail skincare lines that address a wide spectrum of concerns. Key categories include:
• Hydration and radiance - Aqua Vital: Hyaluronic Acid based range to deeply hydrate, moisturise and revitalise skin. The range consist of a full professional and retail range.
• Anti-aging and rejuvenation - 3C Vitamin Glow, Cellular 3 and Epigenesse: Our specialised ranges will deliver great anti-ageing properties and are formulated with growth factors, peptides, antioxidants, epigenetic technology,collagen and apple stem cells aimed at improving texture, firmness and elasticity.
• Luminosity/depigmentation line: Newly reformulated to treat pigmentation at the source. Formulated with tranexamic acid, niacinamide and Spongilla spicules for a clearer and more even skin tone.
• Sensitive & Reactive skin - Harmony: Formulated with pre- and post biotics to treat all types of skin sensitivity and redness, taking care of the skin's microbiome.
• Targeted serums and boosters: Including eye serums, lash & brow serums, and CC creams for specific needs.
• Professional-only products: High-strength actives for spa and clinic use, often combined with signature massage protocols or electro-therapies to enhance results. Our range of Dermo Peel treatments all formulated with Spongilla Spicules delivers exceptional results with microneedling benefits without the downtime.
• Silhouette range: Our cosmeceutical body line is ideal to treat cellulite, stretch marks and water retention. Perfect for any salon or spa as no water is needed for the luxurious Parafango body treatment. Homecare enhances results.
• Lab-Developed Cosmeceuticals: Products formulated with high concentrations of proven actives and designed for biological efficacy, not just surface effect.
• Time-Release Technology: Encapsulation methods that ensure ingredients release gradually, achieving deeper and longer-lasting results.
• Professional & Consumer Lines: Suites of products tailored for both spa/professional use and at-home routines, bridging the gap between clinical and everyday care.
• Quality Standards: Manufactured in facilities that adhere to ISO 9001 and GMP pharmaceutical standards, underscoring a commitment to highgrade formulation and consistency.
• Global Experience with Local Support: Decades of presence in South Africa, including stock availability, therapist training, and industry partnerships that enhance accessibility and education.
• Extensive Loyalty Program: The loyalty program is designed to give back to salons to grow retail business, incentivise therapists and even include trips to Spain.
In essence, Anesi Lab marries scientific rigour and luxury sensorial experience, offering skincare that performs at both a clinical and aesthetic levelideal for spa integration and targeted home care alike.
Join the Anesi Lab Revolution!
Tel: 011 262 2451
email: online@limelighthb.co.za Website: www.anesilab.co.za







As Biomedical Emporium celebrates its 10th anniversary, the milestone reflects far more than time in the market. It marks a decade defined by scientific rigour, purposeful innovation, and a clear commitment to advancing professional skin health through biotechnology and evidence-based formulation.
Founded by Dr Judey Pretorius, Biomedical Emporium was established with a distinct vision: to elevate dermal and regenerative care by bridging advanced biomedical science with practical, clinically relevant application. From its inception, the company positioned itself at the intersection of aesthetics, wound healing, and regenerative medicine—an approach that continues to shape its identity today.
Dr Judey is a highly accomplished Biomedical Scientist and product development specialist, with extensive experience spanning acute, chronic, and post-surgical wound healing, regenerative medicine, and cell therapy. Her academic background includes a Master’s degree in Genetics and Molecular Biology, followed by a PhD in Pharmaceutical Chemistry, Medicine Development and Design, as well as an Advanced Diploma in Dermal Aesthetics. This rare combination of scientific depth and aesthetic expertise has been foundational to Biomedical Emporium’s credibility and direction.
Before founding the company, Dr Pretorius built a
distinguished career as a Research and Development Formulation Scientist, where she was responsible for the scientific and biomedical formulation of therapeutic products across premium cosmeceutical, pharmaceutical, and medical device brands. Her work contributed to the development of advanced products designed to perform within complex biological environments—experience that directly informs Biomedical Emporium’s formulation philosophy.
Today, Biomedical Emporium operates as a biotechnology company specialising in advanced biological product formulation, cell culture processes, tissue engineering for wound healing, and advisory services within regenerative medicine. Central to its offering is Dr Pretorius’ unique formulation approach, which focuses on products designed to work symbiotically and synergistically, stimulating the skin’s own repair and rejuvenation mechanisms rather than overriding them.
This scientific integrity has resonated strongly with professionals seeking solutions that prioritise longterm skin health over short-term cosmetic effect. Over the past decade, Biomedical Emporium has earned the trust of clinicians and therapists by consistently delivering formulations grounded in biology, supported by ongoing research and development.
The 10th anniversary celebration brought together
industry peers, partners, and collaborators to reflect on the journey so far. More than a commemorative event, the function highlighted the relationships and shared values that have supported the company’s growth—education, integrity, and a commitment to advancing standards within the professional skincare and wellness space.
In an industry shaped by rapid innovation and evolving client expectations, Biomedical Emporium’s sustained relevance speaks to its ability to remain adaptive without compromising its scientific foundation. Its success lies in resisting transient trends while continuing to refine and expand its expertise in regenerative and aesthetic care.
As Biomedical Emporium enters its second decade, it does so with a strong sense of purpose. Guided by Dr Judey Pretorius’ vision and scientific leadership, the company remains focused on meaningful innovation, professional education, and the continued development of solutions that respect the intelligence of skin biology.
Ten years on, Biomedical Emporium stands as a testament to what can be achieved when science, integrity, and long-term thinking guide every stage of growth.
For more information: www.biomedicalemporium.com







Biomedical Emporium introduces the Helix Series, a four-step skincare system developed to support individuals struggling with acne-prone skin, persistent breakouts, and inflammation-related skin concerns. Grounded in dermatological science, the Helix Series addresses acne as a multifactorial condition rather than a surface-level concern.
Acne vulgaris commonly emerges during adolescence due to hormonal changes but increasingly affects adults, particularly women. Its development is driven by excessive sebum production, hyperkeratinisation, microbial imbalance — especially Cutibacterium acnes — and inflammation within the pilosebaceous unit. When left untreated, inflammatory lesions can result in long-term scarring and post-inflammatory pigmentation.
The Helix Series was formulated to intervene at each of these contributing factors. Used as a complete system, the four steps work synergistically to regulate sebum production, reduce bacterial colonisation, calm inflammation, and restore the skin’s natural pH balance of approximately 5.0, supporting barrier integrity and long-term skin health.
Designed with tolerability in mind, the Helix Series is suitable for sensitive skin and can be used alongside oral isotretinoin therapy under professional supervision. All formulations are free from parabens, artificial colourants, and added fragrance.
Key active ingredients include salicylic acid, which penetrates the hair follicle to reduce oil production, promote exfoliation, and control microbial activity, and succinic acid, known for its anti-inflammatory, antimicrobial, antioxidant, and hydrationsupporting properties. Niacinamide and zinc oxide assist in calming inflammation, supporting healing, and balancing sebum levels, while allantoin and tocopherol acetate (vitamin E) help soothe the skin and strengthen barrier function. Tea tree oil provides additional antimicrobial support, and menthol offers a gentle cooling effect while enhancing ingredient penetration.
With the Helix Series, Biomedical Emporium delivers a balanced, science-led approach to acne care — prioritising efficacy, skin tolerance, and long-term skin integrity.


Lamelle Pharmaceuticals is redefining the skincare supplement category with the launch of Matricoll ECM® a premium, science-driven oral anti-ageing supplement engineered to repair, rebuild, and protect the skin from within. Leveraging advanced bio-active peptide technology, Matricoll ECM® offers a multitargeted approach to extracellular matrix (ECM) regeneration, setting a new benchmark for efficacy in ingestible skincare.
Skin ageing is characterised by the progressive breakdown of the ECM, the structural network composed primarily of collagen, elastin, and hyaluronic acid (HA). While typical oral supplements rely mainly on hydrolysed collagen, these larger peptides are often poorly absorbed, with only an estimated 10 - 30% reaching systemic circulation. This limited bioavailability often translates into incomplete or delayed skin benefits.
Matricoll ECM® overcomes these limitations through a sophisticated combination of highly bioavailable peptides and synergistic actives, including collagen tri- and di-peptides, elastin di-peptides, low-molecularweight hyaluronic acid, astaxanthin, and niacinamide.
This multi-layered, ECM-focused strategy supports accelerated skin repair, reduces inflammation, combats oxidative stress, and reinforces the skin barrier. Clinical evaluations demonstrate
improvements in hydration, elasticity, wrinkle depth, and overall radiance, with superior absorption and potency compared to conventional collagen supplements.
A new benchmark in ingestible skin science through comprehensive extracellular matrix (ECM) restoration supported by research-grade peptide technology. Designed for efficiency and ease of use, the formulation offers convenient dosing while providing results comparable to procedural interventions, without downtime, invasiveness, or recovery. Its advanced bio-active peptides are engineered for direct absorption and remain effective even in the presence of gut microbiome imbalance, ensuring consistent, predictable outcomes. Beyond visible skin renewal, the systemic benefits extend to overall cellular resilience and metabolic support. Clinical data demonstrates measurable improvements, including up to a 25% increase in elasticity, 30-40% boost in hydration, 20% reduction in wrinkle depth, 20 - 30% enhancement in dermal density, and a 15 - 20% improvement in complexion luminosity. These accelerated, high-impact results are driven by innovative peptide science that elevates oral skin supplementation to a new level of performance.
What can you expect to see on your skin?
•Noticeably smoother, firmer, more resilient skin
with improved elasticity and bounce.
•Rebuilt skin structure promoting regeneration and delayed ageing.
•A healthier, more youthful complexion protected from environmental damage.
•Revitalised, hydrated, radiant skin due to improved cellular activity and metabolism
•Enhanced results from existing skincare and professional treatments through deeper skin receptivity
“Ingestible beauty has historically focused on collagen in isolation, but ageing is a whole-ECM phenomenon. Matricoll ECM® shifts the paradigm by delivering coordinated biological signals that stimulate collagen, elastin, and hyaluronic acid production simultaneously ,” says Dr Bradley Wagemaker, Medical Director and Product Formulator, Lamelle Pharmaceuticals. “For the first time, we can offer a supplement that mirrors the sophistication of in-clinic interventions, giving patients a scientifically validated way to rebuild skin from its foundational matrix outward.”
Repair. Rebuild. Protect. Choose Matricoll ECM® because real, lasting results begin deeper than the skin surface.
For more information: Website: www.lamellepharmaceuticals.co.za




Born nearly 50 years ago from the visionary work of biologist and physiotherapist Yvan Allouche and Josette Allouche, Biologique Recherche has, from its inception, distinguished itself through formulations tailored to the Instant de Peau®-a skin condition in constant evolution, shaped by season, climate, lifestyle, health, and stress levels.
In an industry traditionally guided by age and skin type, this singular approach reflects a deeper philosophy: to apply the most advanced scientific knowledge and technologies to support and optimise the skin's natural functions. Never working against the skin, but always with it, Biologique Recherche continues to create highperformance formulations designed to visibly enhance the skin's appearance.
Driven by this ambition to meet specific skin needs through innovation, the VIP O2 range was first introduced in 1998. Inspired by the process of liquid respiration, Yvan Allouche developed formulas to support skin oxygenation in conditions where it is compromised-particularly in urban environments exposed to pollution and oxidative stress.
Committed to continuous questioning and progress, Biologique Recherche is reinventing the VIP O2 range in 2025.
This new generation of oxygenating skincare introduces an exclusive, patented complex developed by Biologique Recherche's Research & Development teams, opening a new field of exploration into oxygen's essential role within the skin's ecosystem.
By optimising epidermal cellular oxygenation, VIP O2 supports skin metabolism and energy production, essential to proper skin function. The range restores hydration, radiance, and texture. Day after day, the skin's appearance is revitalised, revealing its natural beauty.
Rather than supplying oxygen at the surface, Biologique Recherche chose a fundamentally different approach: helping the skin better utilise the oxygen already available to it.
This targeted strategy is rooted in physiology. At its core lies the mitochondria-the site where oxygen is converted into energy, and where metabolic slowdown begins.
Biologique Recherche's answer is a unique, patented oxygenating complex developed by its R&D laboratories. Formulated around melatonin and strengthened by two complementary co-bioactives, the complex amplifies the skin's endogenous signals.
Not to bypass natural mechanisms, but to restore them.
Not to overstimulate, but to reactivate mitochondrial respiration where it weakens. Not to force energy production, but to optimise ATP synthesis without inducing additional oxidative stress.
With this new patented VIP O2 complex, Biologique Recherche delivers a precise, physiologically respectful solution: restoring epidermal bioenergetics through direct support of mitochondrial oxygen metabolism.
Formulated with the VIP O2 complex, the products act on the three fundamental markers of skin quality: hydration, radiance, and texture.
With a strengthened skin barrier, the epidermis is better equipped to defend against external aggressions while maintaining optimal hydration levels. As energetic processes improve, the skin regains a smoother texture and enhanced radiance-visible signs of restored balance and vitality.


Restore moisture, quality and radiance to dull, tired skin. VIP O2 offers a complete facial routine, as well as essential products for body and hair beauty.
LAIT VIP O2 - Active cleansing milk
MASQUE VIP O2 - Active moisturizing mask
CRÈME VIP O2 - Active moisturizing cream
CRÈME CONTOUR DES YEUX VIP O2 - Active hydrating eye contour cream
FLUIDE VIP O2 - Active hydrating serum
ÉMULSION CORPS VIP O2 - Moisturizing and protective Emulsion with oxygenating complex




Why reformulate the VIP O2 range?
At Biologique Recherche, oxygen has been central to our approach for nearly 30 years, since the creation of the original VIP O2 range. What has evolved today is not the importance of oxygen itself, but our scientific understanding of how the skin uses it.
Over the past three decades, research has advanced significantly, particularly in the identification of new biomarkers-measurable indicators that reflect the biological condition and activity of the skin. These discoveries allow us to observe biological responses with far greater precision and to design more targeted, more effective interventions.
This progress has given rise to what we now call precision skincare: a scientific approach focused on optimising the skin's natural functions by activating the right mechanisms, at the right time, and in the right place. Reformulating VIP O2 was a natural step in applying these advances to better address skin imbalances linked to oxygen utilisation.
Which biomarker did you focus on?
Around ten years ago, scientific research reached a major turning point with the establishment of key frameworks explaining biological ageing. Several fundamental mechanisms were identified as root causes, among which mitochondrial dysfunction is now recognised as one of the most significant biomarkers.
Mitochondria-often described as the cell's “powerhouses”-are responsible for producing ATP (adenosine triphosphate), the body's primary source of biological energy, using oxygen through a process known as oxidative phosphorylation.
When mitochondrial function declines, cellular activity becomes disrupted. Energy production decreases, biological signalling is altered, and metabolism
slows. Clinically, this translates into dull, uneven skin, irregular texture, reduced radiance, and compromised hydration.
Our Research & Development teams therefore explored how to support ATP production by improving oxygen utilisation within mitochondria, particularly in keratinocytes-the structural cells of the epidermis. This led us to investigate a lesserknown endogenous molecule at the skin level: melatonin.
Can you tell us more about the role of melatonin in the skin?
Although present in very small quantities in the skin, endogenous melatonin plays a multifaceted role. Its antioxidant properties are well established, as is its ability to modulate inflammatory responses by limiting the release of pro-inflammatory cytokines. Beyond these protective effects, melatonin also plays a key role in regulating mitochondrial function.
Our research showed that in keratinocytes, melatonin enhances mitochondrial oxygen uptake, activates enzymatic complexes within the respiratory chain, and increases ATP production. This mechanism goes far beyond surface-level oxygenationit reactivates the skin's energy metabolism by harnessing an existing physiological process.
How was the new patented VIP O2 complex formulated?
We developed a synergistic complex combining vectorised melatonin with two carefully selected cofactors designed to amplify ATP synthesis. Our studies demonstrated that this complex directly targets cellular respiration in keratinocytes, which are particularly vulnerable to mitochondrial decline.
Its efficacy was evaluated on skin explants, where we observed a significant increase in mitochondrial respiratory chain activity, indicating improved oxygen utilisation and higher ATP production compared to melatonin alone.
Who is this collection for?
The VIP O2 range is suitable for all skin types, with particular relevance for skin exposed to aggressive external factors such as pollution, UV radiation, chronic stress, and imbalanced lifestyles. By reinforcing the skin's resilience to daily stressors, the range enhances overall skin quality and supports a healthier, more radiant complexion.


By Dr Des Fernandes - Plastic Surgeon and Visionary Co-Founder of Environ Skin Care


While most people associate skin ageing with time or sun exposure, a growing body of research points to a more insidious culprit: inflammageing - a form of chronic, low-grade inflammation that accelerates biological ageing from within.
According to Dr Des Fernandes, founder and scientific director of Environ Skin Care, “Ageing isn't just about counting birthdays. It's a biological process deeply shaped by the cumulative effects of stress: emotional, environmental, and biochemical.”
Inflammageing refers to the persistent, invisible inflammation triggered by stressors like pollution, UV exposure, poor sleep, emotional burnout, and even certain diets. Unlike acute inflammation, which is part of the body's healing response, chronic micro-inflammation wears the skin down over time, degrading collagen, disrupting the skin barrier, and impairing its ability to regenerate.
“Think of your skin as the canvas of your life,” says Dr Des. “When stress becomes chronic, the skin starts showing the effects: dullness, fatigue, sensitivity, and early signs of ageing.”
Modern science now recognises the neuroendocrine function of skin and its direct link to the brain via the HPA (hypothalamic-pituitaryadrenal) axis. This is the body's stress response
system. When triggered too often, it leads to excess cortisol, a hormone that can break down collagen, slow healing, and leave the skin in a prolonged state of inflammation.
Solé Joubert, Global Education Manager at Environ explains: “Skincare professionals see this every day: clients with good routines but unresponsive or prematurely ageing skin. The issue isn't the products; it's the biological exhaustion beneath the surface.”
Rather than masking the symptoms, skin longevity depends on restoring function and resilience at a cellular level. This means supporting the skin's ability to defend, regenerate, and adapt under pressure.
Kayle Ragoobar, Head Chemist at Environ, notes: “One of the biggest breakthroughs in this space is the rise of neurocosmetics. These are ingredients that actively target the brain-skin-stress loop.” Environ's own innovation in this space is Seriénce® Night Serum, a scientifically formulated serum designed to intercept the skin's stress cycle. Its key ingredients include Neurophroline®, which helps reduce cortisol levels in the skin and stimulates beta-endorphins, the skin's natural “feel-good” molecules, as well as Malachite extract, a mineral antioxidant that boosts the skin's detox defenses and lends the formula its calming blue hue. The formulation also features Argireline® Amplified, a pioneering peptide with proven multi-action
effects on muscle relaxation to visibly improve the appearance of expression lines and sagging. In addition, Matrixyl® Morphomics™ is clinically shown to stimulate collagen production, helping to reduce the appearance of stubborn vertical lines. Together, these scientifically advanced ingredients work in synergy to support skin resilience, relaxation, and youthfulness.
If you're wondering whether inflammageing is affecting your skin, look for signs such as:
• Dullness or lack of radiance
• Skin that feels fragile or depleted, not just dry
• Early fine lines and wrinkles
• Sensitivity that's hard to calm
• Post-inflammatory pigmentation that lingers
“These are not just aesthetic concerns,” says Joubert. “They're signs that the skin is tired on a cellular level. Inflammageing is the whisper before the scream.”
As the stress of modern life shows no signs of slowing, addressing the brain-skin connection may be one of the most powerful ways to protect and preserve skin vitality. “We believe in going deeper than the surface,” says Dr Des. “Skincare isn't just about looking younger. It's about keeping the skin biologically healthy and adaptive for longer.”
For further information, visit our website www.environskincare.com









Twenty-five years ago, Professional Skin Care Lab opened its doors with a simple but powerful mission: to change lives by transforming skin and restoring confidence. What began as a modest skincare studio has, over the last quarter-century, evolved into one of Johannesburg's most sought-after aesthetic and skin-health practices - known for its personalised approach, clinical expertise, and unwavering commitment to results.
Founded by Gina, Professional Skin Care Lab was built on a passion for understanding the deeper story behind every skin concern. “Skin is emotional,” Gina shares. “It affects how you show up in the world. From the very beginning, I didn't just want to treat skin - I wanted to empower people.”
Professional Skin Care Lab's journey has been shaped by the belief that no two skins are alike. Gina's reputation grew rapidly as she developed her signature bespoke treatment protocols - long before customised skincare became a trend. Her approach blends clinical science, advanced modalities, and a deep, intuitive understanding of each client's lifestyle, health, and emotional wellbeing.
From microneedling and PRP to Tixel, Xela Redermalization, medical-grade chemical resurfacing and LED therapy, the practice integrates leading-edge technologies with Gina's two-and-ahalf decades of hands-on mastery. “Technology enhances what we do,” she says. “But the therapist's insight and the relationship with the client will always come first.”
A defining element of the business is its commitment to education. Gina has trained therapists, medical professionals, and up-and-coming practitioners, believing firmly that education is the heartbeat of the industry.
The heart of the brand's longevity lies in its loyal community. Many clients have been with Professional Skin Care Lab for 10, 15, even 20 years. Generations of families have entrusted their skin to Gina, known for her warmth, intuition, and ability to make every person feel seen.




The 25-year celebration was held in 2025 and brought together industry partners, clients, and colleagues. The evening honoured the evolution of the business, the relationships built over time, and the impact of personalised, results-driven skincare. It also acknowledged the contribution of the Professional Skin Care Lab team, whose passion supports the brand every day.
As Professional Skin Care Lab steps into its next chapter, Gina is focused on deepening her educational impact, evolving treatment protocols, and expanding her private-label skincare linebeginning with the launch of Pre + Pure Cleanse, her first product.
“I feel more inspired today than I did 25 years ago,” says Gina. “Helping someone feel good in their skin still brings me the same joy - that will never change.”
For more information: Tel: 011 447 4874
Website: www.iprofessionalskincarelab.co.za





In a world where longevity is increasing, the concept of ageing has undergone a profound transformation. No longer seen as a period of decline, ageing is increasingly viewed as an opportunity for growth, exploration, and vitality. This shift in perspective has sparked a revolution in the spa and wellness industry, where innovative approaches to ageing well are emerging as key trends. LNE explores these trends and envisions future directions in the pursuit of holistic wellness for an ageing population.
Holistic Wellness Programs: Traditional spa treatments are evolving into comprehensive wellness programs tailored specifically for ageing individuals. These programs encompass not only physical rejuvenation but also mental and emotional wellbeing. They often include activities such as yoga, meditation, nutritional counseling, and mindfulness practices, offering a holistic approach to healthy ageing.
Integrative Medicine: Integrative medicine, which combines conventional treatments with complementary therapies, is gaining traction in the ageing population. Spas are incorporating modalities such as acupuncture, chiropractic care, and herbal medicine into their offerings, recognizing the importance of addressing the body's interconnected systems for optimal health.
Technology Integration: Technology is playing an increasingly prominent role in ageing well initiatives. From wearable fitness trackers to virtual reality relaxation experiences, spas are leveraging technology to enhance the wellness journey of their guests. Advanced skincare devices, genetic testing for personalized health recommendations, and telemedicine consultations are also becoming more prevalent, empowering individuals to take control of their health and ageing process.
Mind-Body Connection: The mind-body connection lies at the heart of ageing well practices. Spas are incorporating therapeutic techniques that foster mental resilience and emotional balance, such as cognitive-behavioral therapy, stress management workshops, and art therapy. These modalities help individuals navigate the psychological aspects of ageing, promoting a sense of purpose and fulfillment in later life.
Sustainable Wellness: As environmental consciousness grows, sustainable wellness practices are becoming increasingly important in the spa industry. From eco-friendly facilities to organic skincare products, spas are prioritizing sustainability in their operations. Additionally, wellness programs that emphasize connection to nature, such as forest bathing and outdoor meditation sessions, are gaining popularity for their restorative benefits.
As humanity progresses into an era of extended lifespans, the quest for optimal ageing becomes paramount. No longer confined to merely surviving,
individuals seek to thrive throughout their extended years. This paradigm shift catalyzes the evolution of spas and wellness centers into hubs of innovation, where cutting-edge technologies and personalized approaches converge to sculpt a future where ageing is synonymous with vitality and fulfillment. Let's delve into the promising avenues awaiting us in the realm of ageing well.
Personalized Wellness: At the nucleus of the future of ageing well lies personalization. Imagine a spa experience tailored precisely to your unique biology, preferences, and goals. Thanks to advancements in artificial intelligence (AI) and big data analytics, this vision is swiftly becoming a reality. By harnessing the power of AI algorithms, spas of the future will glean insights from vast troves of health data, encompassing everything from genetic predispositions to lifestyle habits. Armed with this knowledge, wellness practitioners will craft bespoke plans encompassing nutrition, fitness regimens, stress management techniques, and beyond. Every aspect of the wellness journey will be meticulously calibrated to optimize vitality and longevity, ensuring that each guest embarks on a path uniquely suited to their needs.
Regenerative Therapies: The dawn of regenerative medicine heralds a paradigm shift in the ageing narrative. Gone are the days when agerelated degeneration was accepted as an inevitable consequence of the passage of time. Instead, spas of the future will offer a repertoire of regenerative therapies aimed at rejuvenating the body from within. Stem cell treatments, hailed as the vanguards of regenerative medicine, hold the promise of restoring youthful vigor by harnessing the body's innate capacity for repair. Platelet-rich plasma therapy, leveraging the healing properties of blood platelets, emerges as another potent tool in the arsenal against ageing. Furthermore, peptide injections, finely tuned to trigger specific physiological responses, offer targeted interventions to combat age-related ailments. Collectively, these regenerative therapies represent a seismic shift in our approach to ageing, offering a glimpse into a future where age truly becomes just a number.
Brain Health Optimization: In an age where cognitive decline looms as a pressing concern, preserving brain health takes precedence. Future spas will serve as bastions of cognitive optimization, offering a plethora of interventions designed to fortify mental acuity and resilience. Neurofeedback training, a burgeoning field at the intersection of neuroscience and technology, empowers individuals to sculpt their brain activity patterns, fostering enhanced cognitive function. Brain stimulation techniques, ranging from transcranial magnetic stimulation to non-invasive electrical stimulation, hold promise in rewiring neural circuitry and ameliorating age-related cognitive deficits.
Moreover, cognitive enhancement programs, encompassing tailored exercises and cognitive training protocols, equip individuals with the tools to maintain cognitive vitality well into their golden years. By prioritizing brain health, spas of the future pave the way for a future where age is no impediment to intellectual prowess and independence.
Virtual Wellness Experiences: The advent of virtual reality (VR) technology opens a portal to a realm where wellness transcends physical boundaries. Virtual wellness experiences, seamlessly blending immersive technology with age-old wellness practices, democratize access to holistic well-being. Imagine embarking on a guided meditation journey amidst the serene landscapes of distant continents or partaking in a rejuvenating yoga session atop snow-capped Himalayan peaks—all from the comfort of your living room. These virtual escapades not only foster relaxation and rejuvenation but also foster a sense of interconnectedness with the wider world. Moreover, virtual fitness classes, spanning a spectrum of disciplines from high-intensity interval training to mindful movement practices, cater to individuals of all ages and abilities, ensuring that wellness knows no bounds. By harnessing the transformative power of VR, spas usher in an era where wellness becomes an immersive, accessible, and deeply enriching experience for all.
Community-Centered Wellness: In an age characterized by unprecedented connectivity, the importance of community in fostering holistic wellbeing cannot be overstated. Spas of the future evolve into vibrant hubs of social interaction and support, catalyzing the formation of tight-knit wellness communities. Imagine a space where individuals converge not only to rejuvenate their bodies but also to nourish their souls through meaningful connections and shared experiences. Group wellness activities, spanning the gamut from group yoga sessions to laughter therapy workshops, foster a sense of camaraderie and belonging. Educational workshops, led by experts in fields ranging from nutrition to mindfulness, empower individuals to take charge of their well-being in a supportive, communal setting. Furthermore, networking events offer opportunities for serendipitous encounters and the forging of lifelong friendships. By placing community at the heart of wellness, spas of the future become catalysts for social cohesion, combatting the scourge of social isolation and fostering a sense of belonging among ageing individuals.
In conclusion, the future of ageing well brims with promise, propelled by a convergence of cuttingedge technologies and human-centric approaches. Spas and wellness centers stand at the vanguard of this revolution, pioneering new frontiers in holistic well-being. By embracing personalization, harnessing the power of regenerative medicine, prioritizing brain health, leveraging virtual wellness experiences, and fostering community-centered wellness initiatives, we unlock the full potential of ageing—a future where vitality, fulfillment, and joy know no bounds. As we embark on this transformative journey, let us redefine the ageing narrative, ushering in an era where every moment is imbued with vibrancy, purpose, and possibility.


The much-anticipated Resa.K Skin Science range is set to redefine the local skincare landscape. This unisex, cosmeceutical collection marries luxury with accessibility - a scientifically advanced skincare line that embodies integrity, efficacy, and inclusivity.
Formulated and founded by Resa Kahn-Botha, Resa.K Skin Science reflects her philosophy that skincare should be both responsible and transformative. Named after its creator, the brand captures her lifelong commitment to scientific precision, skin barrier health, and the emotional power of self-confidence. Through her formulations, Kahn-Botha continues her mission to change the way people perceive their skin - and themselves.


Designed with South Africa's unique climate and lifestyle in mind, the Resa.K range provides targeted protection against oxidative stress, pollution, high UV exposure, and environmental aggressors. Each product is responsibly formulated, combining scientifically proven actives with sensorial elegance.
At the heart of every formula is a commitment to barrier repair, inflammation control, and cellular rejuvenation - key to addressing concerns such as ageing, pigmentation, and environmental damage.
Although positioned as a premium skincare range, Resa.K Skin Science is competitively priced to ensure that advanced skincare is accessible to more South Africans. From the airless packaging technology that ensures hygiene and product preservation, to the colour-coded system that simplifies the user experience, the brand offers a refined yet approachable routine that fits effortlessly into both minimalist and multi-step skincare lifestyles.
The collection has been meticulously structured to serve every skin type and routine preference:
• Universal Cleanser: A multifunctional gel that removes makeup, cleanses, and tones - suitable for all skin types.
• Enzymatic Exfoliator: A gentle, non-abrasive exfoliant that refines texture and boosts radiance without irritation.
• Booster Range: Potent formulations highlighting a single hero active, designed to target specific skin concerns with precision.
• Serums: Scientifically engineered to address hydration, ageing, and pigmentation at a cellular level.
• Moisturisers: Four high-performance options tailored to different needs - an anti-ageing day and night creams, a pigmentation-correcting moisturiser, and a universal 24-hour hydrator.
• Nutritional Supplements: Including hydrolysed collagen, skin brightening capsules, hair growth support, and enzyme-based anti-inflammatory formulations to enhance skin health from within.
Although the brand bears a female name, Resa.K Skin Science is unisex by design. Guided by the principle that “skin is skin”, the formulations serve both men and women equally - meeting the needs of every lifestyle, from those who indulge in multi-step rituals to those who prefer an effortless two-step regimen.
The Resa.K Skin Science range will officially launch between December 2025 and January 2026, with availability through selected professional clinics and authorized stockists nationwide.
This debut marks a new era in South African skincare innovation - one where scientific excellence, sustainability, and self-belief meet in perfect harmony.
For more information:


Born from a desire to return to simpler, more natural rituals of selfcare.
Founded by two siblings with a shared background in spa therapy, and interior design, we create products that celebrate a slower, more intentional way of living — inspired by the rhythms of nature and the beauty of simplicity.
From our farm in the rolling Midlands of South Africa, we craft and connect with premium retail, spa, and hospitality partners. Explore our full range.
Natural Coffee Scrub Mandarin & Lemon Verbena
A refreshing, skin-smoothing body exfoliant that exfoliates while nourishing with natural oils. Brightens, uplifts, and invigorates leaving skin feeling smooth. Lightly scented with beautiful aromatic notes.
For more info: www.herbage.co.za
In professional skincare, the conversation is shifting from anti-ageing to slow ageing - supporting skin to age well, rather than attempting to erase time. Haylo Botanicals embraces this philosophy through waterless, 100% natural formulations that work with the skin's own rhythms.
Our multi-award-winning Renew Drops Face Oil strengthens the skin barrier and improves resilience using a synergistic blend of African heritage oils rich in essential fatty acids and antioxidants. Paired with Radiant Eye Oil, which targets fragility, dehydration and oxidative stress around the eye area, these formulations encourage long-term skin health.
Slow ageing is not about urgency. It is about consistency, nourishment and respect for the skin.
For more info: www.haylobotanicals.com

DermaFix RetinEye is a results-driven eye treatment formulated to address some of the most persistent concerns around the delicate eye area. Formulated with a synergistic blend of retinaldehyde, collagen amino acids, and mentha suaveolens, RetinEye works to visibly soften fine lines, reduce puffiness, and improve overall hyperpigmentation and texture. Its gentle yet effective Vitamin A derivative supports accelerated cell renewal without unnecessary irritation, making it suitable for long-term, corrective use. With consistent application, the eye area appears refined, brighter, and more resilient. RetinEye delivers targeted rejuvenation where it's needed most, restoring youthful vitality with every application.
For more information: www.dermafix.co.za

Woman & Home Award Winning
Indulge in radiance with Litchi & Titch's, Vit C Melting Balm Mask, a luminous treat for glow-seekers and natural skin care enthusiast's. Packed with plant based ingredients, this transformative balm-to-mask glides on silky-smooth, then morphs into a melt-on-contact veil that hydrates, nourishes and protects. Packed with plant derived Vit C, it brightens dull skin, helps to fade dark spots, and evens out skin tone. Acting as a gentle antioxidant shield, it guards against daily pollution and other toxic build up on the skin. Boasting Bakuchiol, Seaberry Buckthorn and Baobab as key ingredients.
Say Hello to soft, dewy and positively luminous skin. Naturally!
For more info: www.litchiandtitchnaturals.com


Born in Cape Town and guided by the principles of slow beauty, Skin Creamery is a South African skincare brand that believes less truly is more. Created with intention and care, the brand champions a thoughtful approach to skincare - one that prioritises quality, longevity, and respect for both skin and planet.
At the heart of Skin Creamery is a commitment to natural, plantbased ingredients, chosen for their ability to gently nourish, protect, and restore the skin without unnecessary additives. Each formula is designed to work in harmony with the skin's natural rhythms, making the range especially suited to sensitive and reactive complexions. No harsh chemicals, no artificial fragrances - just purposeful skincare that delivers lasting results.
Skin Creamery's minimalist aesthetic mirrors its slow beauty philosophy: refined, considered, and quietly confident. From gentle cleansers to deeply hydrating moisturisers, every product encourages a mindful routine - one that favours consistency over excess and care over speed.
More than skincare, Skin Creamery is an invitation to slow down, reconnect, and treat self-care as a daily ritual rather than a rushed routine.
For more info: www.skincreamery.com


GFIT (Growth Factor Induced Therapy) by AQ Skin Solutions is a clinician-designed stamping protocol that delivers isolated, human-derived growth factors—more accurately described as tissue-specific cell regulators—through controlled micro-channels to activate targeted skin repair. In clinical practice, GFIT is paired with AQ Recovery Serum for immediate and postprocedure support, and AQ Active Serum for ongoing home maintenance.
AQ Recovery Serum is NAPPI coded in South Africa, which may allow patients to claim from medical aid when treatment is appropriately prescribed and supervised. For outcomesdriven practices, the GFIT + Active + Recovery pathway offers PRP-like biological signalling without a blood draw, while remaining standardised, predictable, and easy to integrate into spa and medical-spa menus.
“The GFIT, Recovery and Active combination delivers clear, receptor-level signals for repair,” says Amy Knoetze, CEO of AQ Skin Solutions Africa. “Often referred to as ‘PRP in a bottle’, it uses the same biological language of healing in a stable, clinic-ready format. Tissue specificity is what enables consistent protocols and confident outcomes.”
Skin repair is governed by short-range protein signals that regulate inflammation, collagen synthesis, and barrier function.
AQ formulations contain isolated, fibroblastderived growth factors selected for skin tissue specificity, alongside regulating cytokines and interleukins. This targeted approach delivers precise instructions at receptor level rather than non-specific stimulation. Unlike plant-derived “growth factors,” AQ’s actives are human-derived, GMP-manufactured, and stabilised for potency and consistency.
GFIT delivery uses a sterile dermal stamp to create uniform micro-channels—typically 0.25–2 mm for facial skin—enhancing penetration while minimising tissue trauma. GFIT supports softening of fine lines and crepey texture, gradual firmness through fibroblast activation, refinement of superficial scars, and improved skin vitality, with visible changes developing over 6–12 weeks.
For more information: www.aqskinsolutionssa.com








On 4 October 2025, Cape Town’s iconic Zeitz MOCAA transformed into a gathering ground for those seeking to redefine ageing — as the launch event for Ageless by Design introduced its bold, sciencedriven vision. The occasion presented a powerful message: ageing is inevitable — but decline is not.
Held under the soaring silos and contemporary art surroundings of Zeitz MOCAA, the event drew a curated crowd of health-conscious individuals, wellness professionals, medical practitioners, and curious guests eager to explore a new paradigm in longevity and vitality. The day combined inspiring talks, evidencebased frameworks, personal stories, and opportunities to connect — all within an atmosphere balancing elegance with earnest dedication to better living.
At the core of the summit was the unveiling of the “12 Steps to Extending Healthspan™”, a comprehensive framework developed by Ageless by Design. The organisers challenged the prevailing medical model, which often waits for illness before intervening. Instead, the emphasis is on prevention, personalisation, and optimisation of biology through genetics, functional diagnostics, hormone balance, aesthetics, and lifestyle.
Guests were invited to rethink ageing as a continuum rather than a reactive process. Ageless by Design proposes that everyone deserves a tailored plan — informed by real data, individual biology, and evidencebacked interventions rather than one-size-fits-all solutions. The framework offers clarity around personal biology, actionable wellness steps, and strategies to maintain vitality, mobility, hormonal balance, and mental wellness — proving that decline does not have to be the default.
The event featured a lineup of key contributors aligned with the mission of Ageless by Design, hosted at Terre Paisible Medical Rejuvenation & Spa :
Tania Malan, co-founder of Ageless by Design, drew from her extensive background in regenerative medicine, functional health, and patient-centered care. Her journey from clinical practice to pioneering a preventive, healthspan-focused model anchored the programme in scientific credibility and lived experience.
Shirley van Wyk, Managing Director of Terre Paisible Medical Rejuvenation & Spa, collaborated closely with Tania to develop the Ageless by Design protocol. Her expertise in luxury wellness, metabolic optimisation, and personalised rejuvenation pathways provided a real-world lens for implementing the framework, demonstrating that healthspan optimisation is both scientifically rigorous and experientially transformative.
Dr Elna Rudolph, clinical sexologist and holistic health advocate, explored the role of hormones, emotional wellbeing, and lifestyle choices in sustaining vitality across life’s stages, highlighting that ageing is shaped as much by mindset and behaviour as by biology.
Together with a number of additional speakers, these voices presented an integrated, aspirational, and achievable vision of age management.
Set against Zeitz MOCAA’s dramatic architecture — with its reimagined grain-silo structure, contemporary galleries, and panoramic views from the Ocular Lounge — the launch offered an immersive, refined ambiance.
Attendees engaged with presentations detailing the 12-step healthspan model, real client case studies, and the science underpinning functional medicine, hormone diagnostics, and personalised wellness.
For many, the event felt like a declaration: wellness is a lifelong journey, and each person can influence how they grow older. The harmony of expert insight, medical legitimacy, and community engagement positioned the launch as the beginning of a movement, rather than a brand moment.
In a health landscape that often waits for problems before intervening, Ageless by Design — housed at Terre Paisible Medical Rejuvenation & Spa — presents a shift toward prevention, optimisation, and personalised wellbeing. By weaving together medicine, lifestyle, aesthetics, diagnostics, and wellness philosophy, it offers a structured, science-informed roadmap for intentional, empowered ageing.
As guests departed, the sentiment was unanimous: this is only the beginning. With Tania’s founding vision and Shirley’s collaborative expertise, Ageless by Design has set the stage for a reimagined future of longevity — one guided by clarity, research, personalised care, and the belief that ageing can be intentional, empowered, and deeply fulfilling.
For more information: Website: www.agelessbydesign.co.za

Bringing Performance Protocols into the Spa




In the modern wellness landscape, recovery is no longer exclusive to elite athletes. Spas are increasingly embracing performance-based therapies, translating the science of sports recovery into experiences accessible to anyone seeking enhanced physical function, resilience, and overall vitality. Whether for professional competitors, fitness enthusiasts, or busy professionals navigating demanding schedules, these therapies are designed to accelerate repair, reduce injury risk, and optimise the body's natural regenerative processes.
“Recovery is no longer an afterthought; it is a critical pillar of wellness, just as essential as nutrition, training, or rest.”
Historically, spa therapies emphasized relaxation and indulgence, with benefits largely subjective. Today, the focus has shifted: recovery is now quantifiable, measurable, and integral to performance. Muscular fatigue, joint strain, and nervous system stress are universal experiences, not just athletic concerns. Spa-based recovery protocols provide targeted interventions to restore the body efficiently while maintaining a restorative environment, bridging the gap between sports science and wellness lifestyle.
This focus reflects a broader cultural shift: in an era of constant activity and overstimulation, wellness is functional, proactive, and results-driven. Guests no longer seek only temporary relief; they want lasting improvements in mobility, circulation, strength, and energy management.
Modern recovery therapies often borrow directly from elite sport. Compression therapy, infrared heat, cold immersion, lymphatic drainage, fascia release, and PEMF are central modalities designed to support physical recovery.
• Compression therapy enhances venous return, reduces lactic acid build-up, and decreases swelling.
• Infrared and thermal treatments improve circulation, relax tight musculature, and accelerate cellular repair.
• Cold immersion and cryotherapy reduce inflammation, helping tissues recover after intense exertion.
• Fascial release and deep tissue work restore flexibility, alignment, and soft tissue function.
The spa environment enhances these modalities by integrating sensory immersion, controlled lighting, soundscapes, and aromatherapy, creating a setting where the nervous system can also recover alongside the body.
Physical recovery alone is insufficient for optimal performance. Recovery-focused spas emphasize nervous system recalibration, reducing sympathetic overdrive and activating parasympathetic restorative states.
Techniques such as slow, rhythmical massage, floatation therapy, guided breathwork, and sound immersion allow guests to release tension stored not just in muscles, but in the nervous system itself. Many report improved sleep, better stress management, enhanced focus, and heightened mental clarity, demonstrating that recovery is as much about mind and system coherence as it is about muscles.
Modern spas increasingly integrate biometric tracking and performance assessments to optimize recovery outcomes. Heart rate variability, muscular tension monitoring, and mobility assessments allow therapists to personalize recovery protocols, ensuring treatments align with the guest's physiology, activity level, and recovery goals.
This level of precision ensures not only immediate relief but also long-term resilience. Guests gain insights into their bodies, learn strategies to prevent overuse injuries, and develop awareness of when the body requires intervention - knowledge once reserved for professional athletes.
While elite athletes benefit from these therapies, the broader wellness market is embracing recovery as a preventive and restorative practice. Busy professionals, frequent travelers, and active lifestyle enthusiasts experience cumulative strain similar to athletes. Spa-based recovery programs provide structured, effective solutions for these groups, helping them maintain mobility, reduce fatigue, and sustain energy.
This democratization of performance recovery reinforces an essential principle: restorative wellness is functional, not optional. It empowers individuals to integrate recovery into daily life, making wellness sustainable rather than episodic.
Recovery-focused treatments are rarely standalone experiences. Modern spas integrate them with broader wellness modalities:
• Pre- or post-treatment stretching and mobility sessions enhance range of motion.
• Guided nutrition advice or hydration protocols complement tissue repair.
• Multi-sensory environments enhance emotional restoration, making recovery deeply restorative on both body and mind.
By blending physiological and sensory benefits, spas transform recovery into a complete, immersive journey. Guests leave not only physically revitalized, but mentally calm and emotionally centered.
As research into sports science, physiology, and nervous system health advances, spas are poised to become hubs of integrated recovery. Future offerings may combine AI-guided personalization, real-time biometric feedback, and multi-modal therapies, bridging clinical insight with restorative spa luxury.
The shift towards athlete-informed recovery demonstrates a new ethos in wellness: spas are no longer simply spaces for relaxation - they are active facilitators of human performance, resilience, and vitality.
“Recovery is the bridge between effort and adaptation. Modern spas offer the tools, environment, and guidance to make that bridge safe, restorative, and sustainable.”
Through precise, science-driven, and sensoryimmersive experiences, recovery-focused spas are reshaping expectations of wellness, proving that peak performance is not reserved for athletes - it is accessible to anyone who prioritizes body, mind, and nervous system restoration.

In the evolving world of wellness, when a treatment is delivered can be as important as the treatment itself. Modern spa therapies are moving beyond relaxation alone to incorporate principles long recognised in sports science: recovery is a process, and timing determines its effectiveness. Guests today seek more than indulgence; they want strategically sequenced therapies that accelerate recovery, optimise performance, and support long-term wellbeing.
“In recovery, timing is everything - the right therapy at the right moment unlocks benefits that no single treatment alone can achieve.”
The body is a dynamic system. Circadian rhythms, hormonal fluctuations, metabolic cycles, and nervous system activity all influence how effectively the body responds to interventions. For instance, muscle repair is most efficient when blood flow, hormone levels, and cellular regeneration are at optimal states. Similarly, the nervous system recovers most effectively during certain phases of rest or after targeted preconditioning.
Spas are now applying these principles to schedule treatments for maximum impact, sequencing therapies in a way that complements natural physiological processes. By aligning interventions with the body's rhythms, spas not only enhance the effectiveness of each modality but also accelerate cumulative benefits.
Athletes and active guests provide a clear illustration of the importance of timing. After intense activity, the body experiences microtrauma, lactic acid accumulation, and systemic stress. Immediate
interventions can significantly influence recovery outcomes
• Compression therapy immediately after exercise improves venous return, flushes metabolic waste, and reduces swelling.
• Infrared heat or thermal treatments relax muscles, improve circulation, and promote cellular repair.
• Cold therapy and cryotherapy target inflammation in the acute phase, reducing tissue damage and discomfort.
In the hours following activity, secondary interventions - such as lymphatic drainage, gentle fascia release, and parasympathetic nervous system activationhelp consolidate recovery, release residual tension, and restore equilibrium. Timing these therapies to coincide with the body's natural repair processes maximises both efficacy and comfort.
Physical recovery alone is incomplete. The nervous system, when fatigued or overstimulated, limits healing, reduces sleep quality, and impairs performance. Timing therapies that target the nervous system is therefore critical:
• Evening sessions emphasise parasympathetic activation, improving sleep and emotional balance.
• Midday sessions can strategically release accumulated tension and reset energy levels.
• Sequencing modalities such as slow massage or sound therapy after high-intensity treatments ensures optimal nervous system recalibration.
By intentionally pairing physical and nervous system recovery, spas create a synergistic effectaccelerating repair while enhancing overall wellbeing.
Modern spas increasingly track the effectiveness of timing-focused treatments through guest feedback, biometric data, and wellness questionnaires. Observing markers such as sleep quality, energy levels, circulation, muscle flexibility, and stress reduction allows therapists to fine-tune sequences and scheduling for each individual. This personalised approach maximises results, supports adherence, and demonstrates the measurable benefits of welltimed recovery protocols.
The integration of timing in recovery is transforming spa therapy into a science-driven, results-oriented practice. As technologies such as AI, biometric monitoring, and predictive analytics become more prevalent, spas will be able to precisely schedule interventions for peak physiological response. Multimodal sequences may adapt in real-time to guests' biometrics, creating fully optimised recovery journeys.
This evolution represents a broader cultural shift in wellness: treatments are no longer reactive or singular - they are proactive, intentional, and integrated into daily life. Guests are empowered to maximise performance, longevity, and emotional resilience through structured, strategically timed interventions.
“A spa visit is no longer simply a retreat - it is a carefully orchestrated recovery strategy designed to restore body, mind, and system in perfect synchrony.”
By emphasising timing, modern spas are redefining what it means to recover, proving that wellness is as much about when you act as how you act. In this new paradigm, every treatment is a step toward optimal balance, performance, and sustainable health.



Infrared therapy has quietly become one of the most versatile and sought-after modalities in modern spa and wellness. While its application in clinical settings dates back decades, contemporary spas are using infrared to deliver measurable physiological benefits, enhance relaxation, and support recovery - all within an indulgent, restorative environment.
“Infrared therapy is more than warmth - it is a tool that interacts with the body at a cellular level, restoring, energising, and rejuvenating from within.”
Infrared therapy involves the use of light wavelengths invisible to the naked eye, which penetrate the skin to deliver heat and energy directly to tissues. Unlike traditional heating methods, infrared energy heats the body from the inside out, stimulating molecular activity without excessively warming the surrounding air.
Infrared light is typically divided into three categories:
• Near Infrared (NIR): Shorter wavelengths, penetrates deeply, supports tissue repair and wound healing.
• Mid Infrared (MIR): Targets muscles and joints, improving circulation and reducing tension.
• Far Infrared (FIR): Penetrates shallow tissues, aids detoxification, relaxation, and lymphatic stimulation.
By carefully selecting the appropriate wavelength and session duration, spas can tailor treatments to individual needs, whether for recovery, aesthetics, or relaxation.
Infrared therapy works at a cellular and vascular level. Penetrating light energy increases the kinetic
activity of molecules, which stimulates:
• Blood flow and oxygenation: Expanding capillaries to improve nutrient delivery and waste removal.
• Cellular metabolism: Supporting tissue repair, collagen synthesis, and enzyme activity.
• Lymphatic drainage: Enhancing detoxification and reducing fluid retention.
• Muscle relaxation: Releasing tight fascia and easing joint stiffness.
Scientific studies have shown that infrared exposure can reduce inflammation, support recovery after exercise, and even improve cardiovascular health when incorporated regularly into wellness routines. Its efficacy lies in its ability to deliver targeted thermal energy safely and consistently, supporting both shortterm relief and long-term tissue resilience.
Infrared therapy is adaptable and can be integrated into a variety of spa treatments:
• Standalone Infrared Sessions: Guests lie in infrared saunas or pods for 20-45 minutes. Temperature and wavelength can be customised to individual comfort and desired outcomes.
• Combined Modalities: Infrared can complement massage, lymphatic drainage, or body contouring, enhancing relaxation, tissue pliability, and circulation.
• Pre- or Post-Exercise: Applied before activity to warm muscles or after exertion to accelerate recovery and reduce inflammation.
• Skin Treatments: Integrated into facials or body wraps to improve tone, stimulate collagen, and enhance absorption of active ingredients.
What sets infrared therapy apart is its integration into immersive spa environments. High-tech saunas, infrared pods, and treatment rooms combine targeted wavelengths with aromatherapy, chromotherapy, calming soundscapes, and tactile comforts. This multisensory approach enhances physiological effects while supporting emotional and psychological restoration.
Spa practitioners emphasise that infrared is not just a therapeutic tool - it is a platform for holistic wellness. Guests often report immediate feelings of warmth, relaxation, and mental clarity, while cumulative use supports long-term resilience, tissue health, and energy levels.
As research advances, infrared therapy continues to expand in its applications: anti-aging facials, prehabilitation programs, stress management, and biohacking recovery protocols are now incorporating light therapy for measurable results. Modern spas are leveraging infrared not only for indulgence but for precision wellness - delivering treatments that are both luxurious and scientifically validated.
“Infrared therapy bridges the gap between science and indulgence, offering measurable wellness outcomes in a serene, restorative environment.”
In the contemporary spa, infrared is no longer a niche modality. It has become a cornerstone of integrated wellness, enhancing recovery, promoting relaxation, supporting performance, and improving skin health. For guests seeking holistic, evidencebacked treatments, infrared offers a powerful, versatile, and accessible solution - a gentle, glowing light guiding the body and mind back to balance.






Attending the launch of Popsicle Nail Bar at Fourways Mall felt less like a typical salon opening and more like the arrival of a carefully considered new chapter in South Africa’s beauty landscape. From the moment I stepped inside, the attention to detail and ease of service signalled a brand confident in both its vision and execution.
The space strikes a thoughtful balance between playful and polished. Popsicle’s signature colour palette brings energy and warmth, while the layout and finishes ensure the environment remains calm and comfortable. It is immediately evident that this is not a rushed concept, but one shaped by intention and experience. The overall atmosphere encourages clients to slow down, feel welcome, and enjoy the moment.
A standout element of the Fourways opening was the visible presence of the owners. Engaged, approachable, and genuinely invested, they set the tone for a service culture that feels authentic rather than performative. The team mirrored this energy— professional, friendly, and attentive without being intrusive—creating an experience that felt personal and relaxed. Comfort, often overlooked in nail care spaces, is clearly a priority here.
Technology plays a meaningful role in the Popsicle experience, most notably through the use of augmented reality consultations. The AI-supported colour selection tool allows clients to preview nail shades and designs with impressive accuracy. Choosing a nail colour—often a surprisingly uncertain decision—becomes intuitive and confidence-led. Rather than overwhelming the process, the technology enhances it, allowing for better outcomes and greater satisfaction.
Behind the brand is a compelling collaboration. Popsicle is the creation of Ian Fuhr, founder of Sorbet and a respected authority on service culture, together with Anil and Trisha Bhogayata, who have spent several years developing an extensive Popsicle nail product range. With Fuhr joining forces with this dynamic younger partnership, Popsicle evolves from product innovation into a fully realised nail bar concept designed for scale and consistency.
Hygiene and safety standards are notably elevated. Popsicle operates with medical-grade sterilisation protocols, positioning cleanliness at an international benchmark level. This commitment instils trust and reflects a deeper respect for client wellbeing—an increasingly important consideration in modern beauty services.
Service differentiation continues through a menu of exclusive manicures and pedicures, some of which are not currently available elsewhere in South Africa. The focus is not on novelty alone, but on introducing global innovations in a refined, professional manner. This positions Popsicle as a quiet trend leader rather than a follower.
Extending the experience beyond nails is the newly launched Popsicle Body Care Range. Designed to complement the nail services, the collection elevates fragrance, texture, and sensorial pleasure, reinforcing the brand’s lifestyle positioning.
At its core, Popsicle is built around a people-first philosophy. As Ian Fuhr notes, service is not simply what the brand does—it is who they are. That sentiment is clearly felt throughout the Fourways location. I left not only impressed by the innovation and execution, but genuinely uplifted by the experience.
With locations now open in Fourways and Bedfordview, and a franchise model planned for national expansion, Popsicle Nail Bars set a confident new benchmark—where joy, professionalism, and meaningful service come together with ease.
To book an appointment: www.popsiclenails.com



As client needs evolve beyond physical relaxation alone, spas are increasingly exploring therapies that address mental, emotional, and nervous system wellbeing. One modality gaining traction is Access Bars, a gentle, hands-on treatment that supports clients holistically while offering tangible business advantages for professional spa environments.
Today’s spa-goers arrive with heightened levels of stress, anxiety, and nervous system fatigue. They are seeking experiences that go beyond surface-level pampering to address emotional tension, mental clarity, and long-term wellbeing. According to internationally certified Access Bars Facilitator Sally Harvey, “While clients have long turned to therapists for emotional support, today’s spa-goers need complementary therapies that address these concerns holistically. Access Bars provides relief on multiple levels, helping clients relax, reset, and regain balance.”
Access Bars involves gently touching 32 specific points on the head, each believed to store electromagnetic components of thoughts, beliefs, emotions, traumas, and limitations. Activating these points encourages the release of patterns that no longer serve the individual. Clients often report a deep sense of calm, emotional lightness, improved sleep, and mental clarity. Importantly for spa professionals, the treatment requires no force or manipulation, making it suitable for all clients and easy to integrate into existing treatment menus.
Access Bars works at the level of the central nervous system, helping the body shift from stress-dominant states to relaxation and regulation. Typical benefits include:
• Reduced stress and mental overwhelm
• Decreased anxiety and depressive symptoms
• Improved sleep quality
• Enhanced emotional balance
• Greater clarity, focus, and calm
• A profound sense of relaxation and mental reset
Many clients also book sessions for preventive wellness, supporting ongoing resilience, mental clarity, and emotional balance — particularly valuable for those with demanding lifestyles or chronic stress.
While not positioned as a medical treatment, studies provide insight into the observable effects of Access Bars. EEG analyses show increased brain coherence during sessions, associated with deep relaxation and enhanced cognitive function. Dr Hope (2017) reported reductions in anxiety severity by 84.7% and depression severity by 82.7% after Access Bars sessions, alongside measurable increases in brainwave coherence. Similar findings by Dr Jeffrey Fannin (2015) suggest neurological benefits comparable to those achieved by advanced meditators, but realized immediately during treatment.
More recent work by Dr Astrid Vester and biologist Mia DeLuca examined real-time physiological responses, including heart rate variability, blood pressure, and heart–brain coherence. Their results indicated a roughly 60% improvement in heart–brain coherence, reflecting enhanced emotional balance, mental clarity, and nervous system ease.
Access Bars is versatile and simple to implement. It can be offered as a standalone treatment for stress relief, emotional support, or mental clarity; as an add-on to massages and facials to deepen therapeutic effects; or as part of staff wellbeing programmes, helping therapists maintain resilience and morale. Repeat visits often amplify benefits, encouraging ongoing bookings and client loyalty.
The Internationally Certified Access Bars® Course is a one-day, internationally recognised training for


spa therapists, massage therapists, beauty professionals, healthcare providers, and anyone interested in personal or professional growth. Upon completion, participants receive certification, registration on the Access Consciousness website, all necessary manuals and charts, and the ability to practice professionally immediately. Sally Harvey’s hands-on, intuitive teaching extends beyond the curriculum, offering insights into practical application, client management, and business growth. Participants also receive a complimentary online strategy session to deepen learning and explore business opportunities.
Integrating Access Bars into a spa menu addresses the growing demand for mind-body therapies. It supports client wellbeing, enhances the spa’s reputation as a holistic destination, and provides a low-impact, repeatable service that is both profitable and restorative for practitioners. As mental health awareness grows, therapies that combine relaxation with nervous system regulation will increasingly differentiate spas in a competitive market.
Facilitator Bio: Sally Harvey is an internationally certified Access Bars Facilitator with over four years' experience, having trained more than 130 practitioners across the spa, wellness and healthcare industries. With a background in publishing for the beauty, spa and medical aesthetics sectors, she brings a unique depth of industry insight to her training. Her work combines energy-based modalities, intuitive coaching and practical business guidance to support both personal transformation and professional growth.
For further information contact Sally on 0829033396, sally@colourfulconnect.com www.accessbarscourse.colourfulconnect.com







NextHealth presents a unique approach to wellness, sitting at the intersection of spa relaxation and evidence-based health optimisation. Unlike traditional spas, the centre positions itself as a destination for holistic wellbeing, combining personalised treatments with advanced modalities designed to support both recovery and long-term vitality.
The atmosphere at NextHealth is modern, clean, and quietly invigorating. Interiors are bright and minimalistic, with natural wood accents and glasspartitioned treatment zones that create an open yet purposeful environment. The design reflects the centre's philosophy: wellness that is precise, professional, and rooted in science.
What sets NextHealth apart is the breadth of its offerings and the integration of personalised care. Treatments include Vitamin- and NAD+-based IV therapies, cryotherapy, infrared light therapy, and aesthetic services, all curated to meet individual health goals. Whether the aim is energy restoration, immune support, skin vitality, or recovery after physical exertion, each service can be tailored to client needs. The centre also incorporates biomarker
testing and health profiling, providing a data-informed foundation for personalised wellness plans.
A key feature of NextHealth is its focus on approachable, professional guidance. Staff walk clients through each treatment, explaining benefits and expected outcomes, creating a sense of comfort and trust. The combination of advanced therapies, educational support, and professional oversight ensures guests feel informed and supported, even when exploring unfamiliar modalities.
Cryotherapy and infrared treatments are designed to provide immediate sensations of invigoration, while IV therapies deliver targeted nutrient support. These experiences aim to balance visible and physiological benefits, from improved skin tone and hydration to enhanced energy and recovery. Combined, the offerings support both short-term refreshment and longer-term health outcomes.
NextHealth also reflects evolving expectations in wellness spaces. Treatments are designed to extend beyond one-off visits, encouraging a holistic approach to health and recovery. Facilities are accessible and inclusive, catering to diverse age
groups, body types, and wellness levels. The centre balances high-end aesthetics with practical functionality, offering an environment that is both aspirational and approachable.
In a crowded wellness landscape, NextHealth distinguishes itself by bridging spa luxury with proactive, personalised health care. It offers a model where relaxation, scientific insight, and measurable results coexist seamlessly. Guests seeking more than traditional massages or facials will find an experience that integrates multiple modalities into a cohesive, health-focused journey.
Ultimately, NextHealth represents the evolution of modern wellness. Its blend of scientific precision, tailored programming, and thoughtfully designed spaces provides a compelling example of how spas can meet the demands of increasingly informed and discerning clients. For those interested in a holistic, personalised, and results-oriented wellness experience, NextHealth sets a high benchmark for the future of spa therapies.
For more information: www.nest-health.com


Stress is often perceived as an unavoidable part of modern life, but its effects go far beyond momentary discomfort. Functional medicine views stress as a fundamental driver of disease, impacting everything from cardiovascular health to immunity, digestion, and longevity. At Next Health, we recognize emotional health as a major pillar of overall wellness, requiring a comprehensive, personalized approach to stress management.
The body thrives on balance—homeostasis—but stress disrupts this equilibrium, triggering physiological and psychological responses that can lead to chronic disease if left unmanaged. Understanding stress as both a disruptor and a potential tool for resilience allows us to develop strategies that mitigate its harmful effects while harnessing its benefits.
The body's response to stress involves a complex interplay of systems, including the hypothalamic-pituitary-adrenal (HPA) axis. When stress is perceived, the body releases cortisol and adrenaline, preparing for a fight-or-flight response. While this reaction is beneficial in acute situations, chronic stress leads to prolonged elevation of these hormones, resulting in:
Inflammation: Chronic stress increases inflammatory cytokines, contributing to conditions like heart disease, diabetes, and autoimmune disorders.
Neurotransmitter Imbalance: Excess cortisol disrupts serotonin, dopamine, and GABA levels, leading to anxiety, depression, and cognitive dysfunction.
Metabolic Dysfunction: Chronic stress promotes insulin resistance, elevated blood sugar, and metabolic syndrome.
Hormonal Disruptions: Stress impacts sex hormones, thyroid function, and overall endocrine balance, contributing to reproductive issues and fatigue.
Immune Suppression: Elevated cortisol weakens immunity, increasing susceptibility to infections and chronic illness.
A holistic stress management plan must integrate the Wellness Wheel, addressing multiple aspects of health to create sustainable balance:
Chronic stress depletes essential nutrients, leading to deficiencies in magnesium, B vitamins, and omega-3 fatty acids—all crucial for mood stability and cognitive function.
Key strategies include:
• Whole organic foods rich in antioxidants to combat oxidative stress.
• Intermittent fasting and mindful eating to regulate insulin sensitivity.
• Personalized testing (micronutrient analysis, food sensitivity testing) to tailor dietary interventions.
• IV Therapy at Next Health, including Vitamin B Complex and Magnesium, to restore essential nutrients.
2. Movement: Regulating the Stress Response
Exercise is the most effective intervention for reducing stress, improving emotional resilience, and supporting metabolic
health. However, intensity matters: Moderate, consistent movement optimizes stress management, whereas excessive high-intensity workouts may exacerbate stress for already overwhelmed individuals.
Next Health recovery modalities, including cryotherapy and HBOT , support optimal exercise recovery.
Poor sleep worsens stress, inflammation, and cognitive function. Functional medicine prioritizes:
• Sleep hygiene practices (cool, dark room, blue light reduction).
• Targeted supplementation (magnesium, adaptogens, melatonin, L-theanine).
• Sleep apnea screening to identify hidden disruptions.
• NAD+ Therapy at Next Health to enhance mitochondrial function and improve sleep quality.
4. Emotional & Mental Resilience
• Mindfulness, meditation, and breathwork to activate the parasympathetic nervous system.
• Social connection and purpose alignment to mitigate emotional burnout.
• Cognitive behavioral therapy (CBT) and coaching to reframe stress perception.
• Red Light Therapy at Next Health to support brain function and reduce stress.
5. Detoxification: Reducing Internal Stressors
Accumulated toxins exacerbate stress by burdening the liver, endocrine system, and immune response. Strategies include:
• Eliminating environmental toxins (plastics, pesticides, heavy metals).
• Liver support via infrared sauna, glutathione IV therapy, and plasma exchange.
• Reducing alcohol and processed food consumption to minimize internal inflammation.
• Therapeutic Plasma Exchange at Next Health to remove inflammatory proteins and optimize cellular health.
The key to optimal emotional health is a multi-layered, proactive approach:
• Move daily (prioritize Zone 2 exercise for stress modulation).
• Eat an anti-inflammatory diet (whole, nutrient-dense foods, omega-3s, adaptogens).
• Prioritize sleep (consistent routine, optimize light exposure, targeted supplementation).
• Use wellness technologies (cryotherapy, HBOT, infrared sauna, red light therapy, IV therapy).
• Develop emotional resilience (mindfulness, therapy, breathwork, social support).
• Regularly assess biomarkers to tailor interventions (cortisol, inflammation, gut health, hormones).
By integrating a functional medicine approach with Next Health’s cutting-edge wellness therapies, you can optimize health, mitigate stress, and enhance longevity. Stress may be the root of disease, but with the right tools, it can also be a gateway to resilience, vitality, and optimal well-being.






Wellness is no longer confined to clinics or spas — it has become mobile, personalised, and medically grounded. IVGo is leading this shift in South Africa, providing a mobile IV wellness service staffed exclusively by registered nurses, allowing clients to prioritise health wherever they are. In today’s fast-paced world, where time is precious and health-conscious lifestyles are increasingly common, IVGo brings clinical care straight to homes, offices, hotels, or events — efficiently, safely, and with tailored attention.
What sets IVGo apart is its uncompromising commitment to care and quality. Every appointment begins with a consultation to understand each client’s individual goals, whether hydration, immunity, energy, or recovery. On the day of the session, every step — from setup to infusion — is delivered with care, precision, and professionalism. Clients are supported throughout, and follow-ups the next day ensure satisfaction and monitor progress, making the experience seamless and stress-free.
Why mobile IV therapy works lies in its efficiency and immediate impact. Administered intravenously, nutrients bypass the digestive system and enter the bloodstream directly, offering faster absorption than oral supplements. This makes IV therapy highly effective for a variety of needs:
Immune support: High doses of vitamin C, zinc, and antioxidants help strengthen defenses and aid recovery from colds or flu.
Hydration and recovery: Rapid rehydration after
exercise, travel, or dehydration supports cellular function and overall wellbeing.
Energy and mental clarity: B vitamins, amino acids, and other targeted nutrients can reduce fatigue and enhance focus.
Beauty and skin health: Antioxidants such as glutathione and vitamin C promote clearer, glowing skin by aiding cellular repair from within.
Preventive wellness: Regular infusions support general health, particularly for those with demanding lifestyles or nutrient depletion concerns.
Globally, mobile IV therapy is rapidly gaining traction, particularly in urban centres where convenience, efficiency, and personalised wellness solutions are highly valued. Across North America, Europe, Asia-Pacific, and Australia, busy professionals, athletes, and wellness-conscious individuals increasingly embrace on-demand IV treatments as part of a proactive approach to health. What is new is not the therapy itself — long used in hospitals for dehydration and illness — but its application for wellness in familiar, comfortable spaces under the supervision of qualified nurses.
IVGo stays ahead of the curve by offering advanced therapies, including restorative peptides and NAD+ infusions. Partnering with trusted compounding pharmacies and integrative medicine practitioners, IVGo delivers sciencebacked, preventative, and performance-enhancing treatments directly to clients. This combination of innovation and clinical expertise transforms mobile
IV therapy from a convenience trend into a credible, medically grounded wellness option.
Safety and comfort are central to IVGo’s approach. Registered nurses administer all treatments following medical-grade protocols, ensuring correct dosing, aseptic technique, and careful monitoring. Clients can receive infusions in the privacy and comfort of home, office, or event settings — making wellness accessible without compromising professionalism or safety.
Beyond individual use, IVGo services are wellsuited to corporate wellness, retreats, sports events, and private gatherings. Customised sessions can support employee health initiatives or group recovery, integrating preventative care into daily life without disrupting routines.
As mobile IV therapy continues to expand, IVGo exemplifies the future of wellness: personalised, clinically grounded, and delivered directly to where clients live and work. In an era where proactive health management is increasingly valued, IVGo turns wellness from a destination into an everyday, sustainable practice — combining convenience, safety, and measurable benefits to body, mind, and skin.
For more information: Tel: 074 604 5555 Website: www.ivgo.co.za

